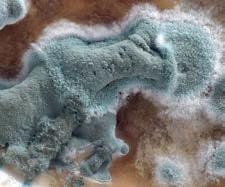
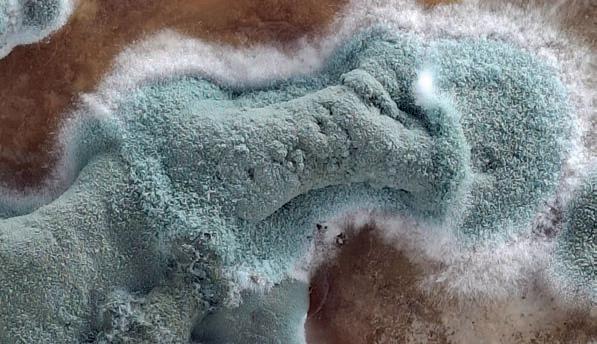

![]()














marbuch-verlag.de
MAGAZIN EXPRESS
Gegründet 1983 von
ERSCHEINT IM MARBUCH VERLAG www.marbuch-verlag.de
Ernst-Giller-Str. 20a, Marburg
Geschäftszeiten: Mo–Fr 9–17 Uhr
VERLAGSLEITUNG
Katharina Deppe, Nicole Martjan
HERAUSGEBER
Norbert Schüren
REDAKTION
Georg Kronenberg (kro) (verantwortl.),
Michael Arlt (MiA), Gesa Coordes (gec), (pe) = Presseerklärung
Tel: 06421/6844-30,-31
Fax: 06421/6844-44
E-Mail: redaktion@marbuch-verlag.de
ONLINE-REDAKTION
Lars Bieker, Johanna Rödiger
Tel: 06421/6844-12
E-Mail: onlineredaktion@marbuch-verlag.de
HERSTELLUNG
Nadine Schrey, Sandra Siebenmorgen
VERANSTALTUNGSKALENDER
Beyza Imamoglu
Tel: 06421/6844-0, Fax: 06421/6844-44
Online-Formular: www.marbuch-verlag.de
ANZEIGEN
Katharina Deppe, Tel: 06421/6844-20
Nicole Martjan, Tel: 06421/6844-11
Peter Weißhaar, Tel: 06421/6844-21
E-Mail: feedback@marbuch-verlag.de
KLEINANZEIGEN (Fließtext)
Beyza Imamoglu
Tel: 06421/6844-68, Fax: 06421/6844-44
Online-Coupon: www.marbuch-verlag.de
DRUCK
Strube Druck & Medien GmbH, Felsberg
Die Urheberrechte der Artikel, Annoncenentwürfe und Fotos bleiben beim Verlag. Keine Gewähr für unverlangt eingesandte Manuskripte oder Fotos. Reproduktionen des Inhalts ganz oder teilweise nur mit schriftlicher Erlaubnis des Verlages. Alle Adressund Programmangaben ohne Gewähr. Es gilt Anzeigenpreisliste Nr. 39 vom 1.1.2024
ABONNEMENT
25 x Ausgabe Marburg 49,– EUR 51 x Ausgabe Marburg 99,– EUR
SCHLUSS
Redaktion: Freitag, 11 Uhr Veranstaltungshinweise: Freitag, 17 Uhr
Kleinanzeigen: Montag, 14 Uhr
Inserate: Dienstag, 12 Uhr
GEPRÜFTE AUFLAGE (1. Quartal 2025)
Marburger Magazin EXPRESS tatsächlich verbreitete Auflage 8.059/Erscheinung
Mitglied der Informationsgemeinschaft zur Feststellung der Verbreitung von Werbeträgern (IVW), Berlin
Marbuch Verlag GmbH
Ernst-Giller-Str. 20a • 35039 Marburg
Geschäftsführer: Norbert Schüren
MAGAZIN ________________________________ 4
Freiwilliges Soziales Jahr __________________6 Bundesfreiwilligendienst____________________6
Engagieren & Ausprobieren________________7
Freiwilliges Ökologisches Jahr______________7
Vielfältige Einsatzmöglichkeiten____________8
FSJ international__________________________9
Musik, die aus der Stille kommt__________10 „Faulpelz“________________________________10
AUSSTELLUNGEN__________________________11
KULTUR TO GO____________________________12
FILM AB!__________________________________14
MARBURG DIESE WOCHE__________________16
FLOHMARKT______________________________20
STELLENMARKT__________________________21
FAHRZEUGMARKT________________________22
Titelbild: Daniel Herskedal
Foto: Knut Aaserud
... Unbezeichnetes Tagebuch, geborgen aus der Asche eines abgebrannten Schuppens an der Lahn. Auf dem Umschlag geritzt: „Sogn’s.“]
„1. April
Frühling kehrt zurück, doch bringt er nicht die süße Verheißung des Lebens, sondern Vorzeichen einer längst vergessenen, unaussprechlichen Macht. Roh und trotzig ragen Spargelstangen in den Marktständen, gleich den Monolithen uralter, gotteslästerlicher Kulte. Ich erkenne die Zeichen. –
3. April
Er erschien wiederum, jener Schemenmann mit zerdrücktem Hut, ,...wär’s ned wieda Zeit ...?‘, hauchte er. Seine Stimme ließ die Schatten der Welt erbeben. Ein alter Pakt fordert – doch mein Herz ist müde.
5. April
Die Tauben kehren heim. Ihre Federn glühen in Farben, die Wahnsinn säen.
An der Brücke hinterlassen sie Zeichen – ätzend, faulig, endgültig.
6. April
Wandte mich flehend an die Stadt, doch ihre Hüter sprechen nur in Paragraphen – tote Worte aus gespiegelten Gesichtern, die kein Licht mehr kennen.
9. April
Ein Hauch verfaulten Gemüses wehte durch den Park. Vom Markt

erklang Gesang in einer Sprache, älter als die Erde.
Unter einer Bank grinste ein Spargel.
11. April
Wandelte durch Wien – oder eine verfluchte Spiegelung davon. Goldene Schemen flirrten im öligen Dunst; Kreisler sang rückwärts aus unsichtbaren Kehlen Lieder der Verdammnis.
Erwachte in Marburg. Meine Hände rochen nach Hollandaise.
13. April
Bot Waffenstillstand. Antwort kam –lautlos, jenseits des Verstehens.
14. April
Harre in dunkler Verbarrikadierung. Draußen lauern die unaussprechlichen Legionen –Stangen, Vögel, gesichtslose Schatten. Unter den morschen Dielen: Flüstern. ,Sogn’s’ “
Michael Arlt

Millioneninvestition an der Erich-Kästner-Schule
Es ist der größte Schulneubau in Marburg seit Jahrzehnten: 20 Millionen Euro investiert die Stadt in die Erich-Kästner-Schule in Cappel. Der Neubau mit mit Klassenräumen, einer Cafeteria und Räumen für Kinderbetreuung ersetzt die alten und bereits abgerissenen Gebäude B und K mit Cafeteria und Betreuungsräumen. Die Arbeiten am Rohbau haben im Sommer 2024 begonnen – nun ist der Rohbau fertig und wurde mit einem Richtfest würdig gefeiert. Das neue Schulgebäude wird im Passivhausstandard gebaut und besteht aus zwei rechteckigen Gebäuden mit einer zentralen Eingangshalle als Verbindungsstück. Das südliche Gebäude ist dreigeschossig, das nördliche hat zwei Etagen. Ein Aufzug sorgt für Barrierefreiheit. Der Speiseraum ist großzügig verglast und kann über eine mobile Trennwand auch zur Eingangshalle hin geöffnet werden. Das ermöglicht verschiedene
Nutzungen. „Wir wollen die Flächen, die uns zur Verfügung stehen, bestmöglich ausnutzen“, so Baudezernent Stadtrat Dr. Michael Kopatz. „So können wir insbesondere den Eingangsbereich der Schule auch für Veranstaltungen im Stadtteil nutzen und das Gebäude so vielfältiger nutzen.“
Mähfreier Mai für mehr Artenvielfalt
Die Stadt Marburg nimmt wieder an der bundesweiten Kampagne „Mähfreier Mai“ („No Mow May“) teil. Das bedeutet, dass die städtischen Grünflächen erst ab Juni wieder gemäht werden. Ausgenommen davon sind Bolzplätze, Kinderspielplätzen, Kindergärten, Schulen, Friedhöfen und Liegewiesen. Der „Mähfreie Mai“ ist Teil einer bundesweiten Kampagne zur Unterstützung der Biodiversität. Wenn der Rasen länger nicht gemäht wird, können Klee, Gänseblümchen, Scharfgarbe, Knoblauchrauke und andere Arten von Wildblumen zur Blüte kommen. Sie bieten Futter für Insekten wie unsere heimischen Wildbienen und Falter. Die etwas höheren Rasenhalme und Blumen bieten zudem Schutz für Insekten und Kleinsttiere. Auf das Mikroklima wirkt sich das höhere Gras ebenfalls positiv aus: Die Erde trocknet nicht so schnell aus, so dass die Bodenfeuchtigkeit länger erhalten bleibt. Dies ist besonders in trockenen Sommern ein großer Vorteil. Durch die Aktion möchte die Stadt Marburg auch Gartenbesitzer motivieren, den Rasen im Mai nicht zu mähen oder eine Ecke Rasen stehen zu lassen, um Artenvielfalt zu fördern und dadurch ein anderes Verständnis für das Mähen zu schaffen. Auch über den Mai hinaus kann etwas für die Artenvielfalt getan werden, indem der Rasen nur teilweise gemäht wird und Inseln stehenbleiben oder eine
Wildblumenwiese mit Regio-Saatgut angelegt wird.
Diskussion mit Wissenschaftsminister Gremmels
„Demokratiesicherung im Fokus der Wissenschaft“ ist das Thema einer Diskussionsrunde mit Hessens Wissenschaftsminister Timon Gremmels am Mittwoch, 30. April um 18 Uhr im Deutschen Sprachatlas der Philipps Universität. Die Veranstaltung markiert den Auftakt der Europawochen und richtet sich an Studierende, Hochschulangehörige sowie interessierte Bürgerinnen und Bürger. Die Europawochen sind eine Veranstaltungsreihe, die das Bewusstsein für Europa, die Europäische Union und ihre Werte stärken soll. Sie finden traditionell im Mai statt, in diesem Jahr vom 30. April bis zum 31. Mai.
Aktuell steht die Europäische Union inmitten bedeutender strategischer Weichenstellungen: Im Sommer 2025 wird ein neuer Entwurf für den Mehrjährigen Finanzrahmen (MFR) erwartet – mit unmittelbaren Auswirkungen auf europäische Programme wie Erasmus+. Diese Entwicklungen nehmen wir zum Anlass, um im Rahmen einer hochkarätig besetzten Veranstaltung die Rolle der Wissenschaft und insbesondere der Europäischen Hochschulallianzen für die Sicherung und Stärkung demokratischer Werte in Europa zu diskutieren.
Die Uhus in der Marburger Elisabethkirche haben Nachwuchs: Seit Sonntag gibt es den Nachweis, dass die Brut erfolgreich war und zwei junge Uhus großgezogen werden. In der Mittagssonne zeigten sich zwei Nestlinge am Fenster
des Brutkastens im Südturm der Elisabethkirche. „Die Jungen dürften nach der Größe und der Entwicklung des Gefieders schon zwei bis drei Wochen alt sein“, erläutert für den NABU Hartmut Möller. Am Tag zuvor konnte beobachtet werden, dass das Männchen aktiv für die Nahrungsversorgung ist und eine Ratte lieferte.
Der Nistkasten, der von NABU-Aktiven ursprünglich für den Wanderfalken im Südturm eingerichtet wurde, ist seit Jahren von den Uhus als Brutort „gebucht“. Außer an der Elisabethkirche sind im Marburger Raum noch weitere Brutstätten bekannt. Laut Möller entwickelt sich die Uhu-Population im Marburger Raum gut. In Uhu-Tagebuch auf www.nabumarburg.de gibt Updates über den Uhu-Nachwuchs. Aktuell laufen für die nächste Brutsaison im Jahr 2026 Planungen, im Südturm eine Live-Kamera zu installieren.
Schutz vor sexualisierter Gewalt im Web
Wie kann ich meine Kinder vor sexualisierter Gewalt im Internet schützen? Wie kann ich erkennen, ob mein Kind betroffen ist? Diese Fragen werden am Dienstag, 6. Mai, von 18.30 bis 20.30 Uhr während eines Online-Vortrages über „Cybergrooming“ thematisiert. Der Vortrag richtet sich insbesondere an Eltern, Großeltern und weitere interessierte Bezugspersonen. Die Teilnahme ist kostenlos.
Unter „Cybergrooming“ ist sexualisierte Gewalt gegen Kinder und Jugendliche im Internet zu verstehen. Täterinnen und Täter gehen dabei oft sehr subtil vor, um Vertrauen gegenüber den Heranwachsenden zu gewinnen und dann sexualisierte Gewalt auszuüben.
Die Teilnehmenden erhalten während des Vortrags Informationen,

wie sie Kinder und Jugendliche vor dieser Gefahr schützen können, wie sie Anzeichen erkennen und was zu tun ist, wenn sie vermuten, dass Heranwachsende betroffen sind. Außerdem gibt es Zeit, um auf Fragen einzugehen. Die Referentinnen sind Lara Beck und Maj Walter von Verein Wildwasser Marburg .
Eine Anmeldung ist unter vhs.link/ScGRtD bis zum 4. Mai notwendig. Die Veranstaltung ist Teil einer Seminarreihe, die sich mit verschiedenen Aspekten von „Cybergrooming“ und der digitalen Gewaltvorsorge befasst. Sie ist eine Zusammenarbeit des Landkreises Marburg-Biedenkopf mit mehreren Vereinen und Institutionen.
Daniel Heck
Erfolg für die Marburger Psychologie: Mit rund 930.000 Euro fördert die VolkswagenStiftung die psychologische Grundlagenforschung von Prof. Daniel Heck im Rahmen der „Momentum“-Förderlinie. Der Forscher und sein Team wollen dazu beitragen, die Wissenschaftsdisziplin Psychologie auf eine solide formale und mathematische Grundlage zu stellen. Dazu sollen aus der modernen KIForschung sogenannte Large Language Models (LLMs) eingesetzt werden, um die überwiegend unscharfen verbalen Beschreibungen der psychologischen Theoriebildung mit exakten mathematischen Modellen zu verbinden. „Dadurch ließen sich deutlich aussagekräftigere psychologische Experimente entwerfen“, sagt der Forscher.
„Dieses Forschungsprojekt adressiert ein zentrales Problem der Psychologie: die Notwendigkeit, theoretische Annahmen präziser zu formulieren und empirisch testbar zu machen. Solche Ansätze
stärken die wissenschaftliche Qualität und ermöglichen belastbare Fortschritte. Mit solchen Projekten entwickeln wir unseren Marburger Profilbereich Geist, Gehirn, Verhalten weiter“, kommentiert Prof. Gert Bange, Vizepräsident für Forschung der PhilippsUniversität Marburg. Die Fördergelder der VolkswagenStiftung gehen zum überwiegenden Teil in zwei Postdoc-Stellen und die Förderung der wissenschaftlichen Vernetzung.
Jugendliche auf ihrem Weg zu ihrem Traumberuf unterstützen, dass ist das Ziel von Claudia Forster. Die Mitarbeiterin der hiesigen Agentur für Arbeit ist die neue Berufsberaterin für die Marburger Schulen. Bei der individuellen Beratung junger Menschen will sie gemeinsam mit ihnen Stärken und Schwächen herauszufinden und den Grundstein für ein erfülltes Berufsleben legen. „Nicht immer führt der gerade Weg ans Ziel. Im Dschungel der Berufswelt gibt es viele spannende Pfade, Abzweigungen und auch mal Kurven – und genau das macht den Weg oft erst interessant“, sagt Forster. Manchmal entdecke man erst unterwegs, was wirklich zu einem passe. Durch ihre langjährige Erfahrung in der Beratung und Weiterbildung kennt Forster die aktuellen Anforderungen des Arbeitsmarktes genau.
Lesefest am 14. Mai
@ Stadtbücherei
Zum Marburger Lesefest im Mai findet eine Bilderbuch-Lesung in der Stadtbücherei statt. Autor Thomas J. Hauk liest am Mittwoch, 14. Mai, um 15.30 Uhr für alle Kinder ab 4 Jahren aus seinem Bil-
derbuch „Die besondere Lolo“. Der Eintritt ist frei. Thomas J. Hauk hat zahlreiche Bücher, Theaterstücke und Filme für Kinder geschrieben. Mit seinen theatralen Lesungen und Performances begeisterte er bereits viele Menschen europaweit. Er ist als Dozent für Schreib- und Kunstworkshops unterwegs, manchmal als Meerwellentänzer oder Caramellbonbonerist. Er gründete ein Theaterhaus in Mannheim und war jahrelang bei der Stiftung Deutsche Kulturlandschaft in Berlin tätig.
kro


Das Freiwillige Soziale Jahr (FSJ) bietet jungen Menschen die Möglichkeit, sich für die Gesellschaft zu engagieren und dabei erste Einblicke in verschiedene Berufsfelder zu gewinnen. Der Einsatz erfolgt unter anderem in Kindertagesstätten, Krankenhäusern, Jugendzentren,
Museen, Sportvereinen oder sozialen und politischen Organisationen. Ziel ist es, berufliche Interessen zu erkunden, praktische Erfahrungen zu sammeln und einen Beitrag zum Gemeinwohl zu leisten. Dabei entwickeln die Teilnehmenden wichtige soziale Kompetenzen wie Teamfähigkeit, Ver-


antwortungsbewusstsein und Empathie, die auch im späteren Berufsleben von großem Nutzen sind.
Ein FSJ dauert in der Regel zwölf Monate, möglich sind jedoch auch Zeiträume zwischen sechs und 18 Monaten. In Ausnahmefällen kann der Dienst auf bis zu 24 Monate verlängert werden. Werden mehrere Freiwilligendienste kombiniert, darf die Gesamtdauer 18 Monate nicht überschreiten. Viele nutzen das FSJ als Orientierungsphase nach dem Schulabschluss, um Klarheit über die eigene berufliche Zukunft zu gewinnen oder Wartezeiten auf Ausbildungsoder Studienplätze sinnvoll zu überbrücken.
Voraussetzung für die Teilnahme ist die Erfüllung der Vollzeitschulpflicht. Weitere Kriterien wie Schulabschluss, Alter, Geschlecht oder Nationalität spielen keine Rolle. In der Regel handelt es sich um einen ganztägigen Dienst. Die Freiwilligen erhalten ein Taschengeld und sind während der Ein-
satzzeit sozialversichert. Dazu gehören die Renten-, Unfall-, Kranken-, Pflege- und Arbeitslosenversicherung. Eltern der Teilnehmenden behalten ihren Anspruch auf Kindergeld. In Abstimmung mit Einsatzstelle und Träger kann das FSJ auch in Teilzeit (über 20 Wochenstunden) absolviert werden. Ein fester Bestandteil des FSJ sind die sogenannten Bildungstage. Bei einem einjährigen Dienst sind 25 solcher Tage vorgesehen. Diese finden meist als mehrtägige Seminare in Gruppen statt. Die Inhalte sind vielfältig und werden in der Regel gemeinsam mit den Freiwilligen geplant. Bildungstage gelten als Arbeitszeit, eine Urlaubsnahme ist dafür nicht erforderlich. Die Einsatzstelle stellt die Teilnehmenden für diesen Zeitraum frei; Kosten für Anreise, Verpflegung und Unterkunft werden übernommen. Neben der fachlichen Weiterbildung steht hier auch der Austausch mit anderen Freiwilligen im Vordergrund, was das Gemeinschaftsgefühl stärkt und neue Perspektiven eröffnet. Während des gesamten Freiwilligendienstes steht den Teilnehmenden eine pädagogische Fachkraft beratend zur Seite.
pe/red
Der Bundesfreiwilligendienst (BFD) bietet Menschen jeden Alters die Möglichkeit, sich freiwillig für das Gemeinwohl zu engagieren. Altersunabhängig können Interessierte in verschiedenen gesellschaftlich relevanten Bereichen tätig werden – dazu zählen unter anderem Soziales, Ökologie, Kultur, Sport, Integration sowie der Zivil- und Katastrophenschutz. Auch neben Schule, Ausbildung oder Beruf kann der BFD absolviert werden, etwa im Rahmen eines Teilzeitdienstes oder ergänzend zu einer Nebentätigkeit.
Die reguläre Dauer eines Bundesfreiwilligendienstes beträgt in der Regel zwölf Monate. Der Dienst kann jedoch flexibel gestaltet werden – eine Mindestdauer von sechs und eine Höchstdauer von 18 Monaten sind möglich. In Ausnahmefällen kann der Einsatz auf bis zu 24 Monate verlängert werden. Für Freiwillige über 27 Jahren besteht zudem die Möglichkeit, mehrfach im Abstand von
fünf Jahren einen BFD zu leisten. Seit einer Gesetzesänderung können nun auch Personen unter 27 Jahren den Dienst in Teilzeit leisten – ein besonderer Nachweis des berechtigten Interesses ist nicht mehr erforderlich. Voraussetzung für die Teilnahme ist lediglich die Erfüllung der Vollzeitschulpflicht. Schulabschluss, Geschlecht, Alter oder Nationalität spielen für die Aufnahme keine Rolle.
Teilnehmende erhalten während ihres Einsatzes ein Taschengeld. Darüber hinaus sind sie in der gesetzlichen Kranken-, Pflege-, Renten-, Unfall- und Arbeitslosenversicherung abgesichert. Der Dienst bietet nicht nur praktische Erfahrungen, sondern auch begleitende Bildungsangebote: Freiwillige unter 27 Jahren nehmen innerhalb von zwölf Monaten an mindestens 25 Seminartagen teil, darunter ein politisches Bildungsseminar, das vom Bundesamt für Familie und zivilgesellschaftliche Aufgaben organisiert wird. Für äl-
tere Teilnehmende ist ein Seminartag pro Monat vorgesehen. Der Bundesfreiwilligendienst stellt somit ein vielseitiges Angebot dar, um gesellschaftliche Verantwortung zu übernehmen, neue Perspektiven zu gewinnen und sich persönlich weiterzuentwickeln.
pe/red


Freiwilligendienste als Chance
Nicht für alle jungen Menschen ist der direkte Weg von der Schule ins Studium oder in die Ausbildung die richtige Wahl. Wer sich Zeit nehmen möchte, um die eigenen Interessen besser kennenzulernen und berufliche Erfahrungen zu sammeln, findet in einem Freiwilligen Sozialen Jahr (FSJ), Freiwilligen Ökologischen Jahr (FÖJ) oder im Bundesfreiwilligendienst (BFD) eine spannende Alternative. Diese Freiwilligendienste bieten zahlreiche Möglichkeiten, sich zu engagieren – ob im sozialen Bereich, im Natur- und Umweltschutz, in der Kultur, Denkmalpflege oder sogar im internationalen
Friedensdienst. So lässt sich nicht nur Gutes tun, sondern auch ganz praktisch in verschiedene Berufsfelder hineinschnuppern. Gerade wer sich noch nicht sicher ist, in welche berufliche Richtung es gehen soll, kann hier wertvolle Einblicke gewinnen. Gleichzeitig lässt sich mit einem Freiwilligendienst auch die Zeit bis zum Studien- oder Ausbildungsbeginn sinnvoll überbrücken – oder sogar Zugangsvoraussetzungen dafür erwerben.
Jedes Jahr entscheiden sich rund 100.000 Menschen in Deutschland für einen dieser Freiwilligendienste.
pe/red

Ein Freiwilligendienst wie das FÖJ bietet Naturerlebnisse und hilft, die Umwelt zu schützen. Foto: BMFSFJ/Bertram
Ein Jahr für Umwelt und Natur
Das Freiwillige Ökologische Jahr (FÖJ) bietet jungen Menschen die Möglichkeit, sich im Natur- und Umweltschutz zu engagieren. Der Einsatzbereich ist vielfältig: Tätigkeiten sind unter anderem in der Landwirtschaft, im Gartenbau, im Umgang mit Tieren oder in der Umweltbildung möglich. Auch pädagogische Aufgaben, etwa die Betreuung von Schulklassen in der Natur, können Teil des Dienstes sein. Teilnehmende erhalten dabei Einblicke in verschiedene Berufsfelder und können berufliche Interessen und Fähigkeiten erproben. Die Einsatzdauer beträgt in der Regel zwölf Monate, ist jedoch flexibel zwischen sechs und 24 Monaten gestaltbar. Teilnahmevoraussetzung ist die Erfüllung der Vollzeitschulpflicht. Ein bestimmter Schulabschluss ist nicht erforderlich. Der Freiwilligendienst steht allen Interessierten offen –unabhängig von Alter, Geschlecht oder Herkunft. Das FÖJ ist in den meisten Fällen ein ganztägiger Dienst. Teilnehmende erhalten ein Taschengeld und sind sozialversichert – inklusive Renten-, Kranken-, Pflege-, Unfall- und Arbeitslosenversicherung. Zusätzlich bleibt der Anspruch auf Kindergeld bestehen. Ein zentraler Bestandteil des FÖJ
sind Bildungstage, die in Form von Wochenseminaren stattfinden. Bei einem zwölfmonatigen Einsatz stehen 25 Bildungstage zur Verfügung. Die inhaltliche Gestaltung erfolgt oft in Abstimmung mit den Teilnehmenden. Die Seminare behandeln unterschiedliche
Themen rund um Umwelt, Gesellschaft und persönliche Entwicklung. Sie gelten als reguläre Arbeitszeit, für die Freistellung durch die Einsatzstelle erfolgt. Reisekosten, Unterkunft und Verpflegung werden übernommen. Während des gesamten Jahres
werden die Teilnehmenden pädagogisch begleitet. Eine Fachkraft steht als Ansprechpartnerin oder Ansprechpartner zur Verfügung und unterstützt bei Fragen rund um Einsatzstelle, Seminare und persönliche Entwicklung. pe/red

FSJ und BFD in der Region
Die Region Marburg-Biedenkopf bietet jungen Menschen, aber auch Interessierten aller Altersgruppen, zahlreiche spannende Möglichkeiten, sich im Rahmen eines Freiwilligen Sozialen Jahres (FSJ) oder eines Bundesfreiwilligendienstes (BFD) zu engagieren. Ob in sozialen, kulturellen, pädagogischen oder medizinischen Bereichen – wer sich für einen Freiwilligendienst entscheidet, profitiert nicht nur von wertvollen praktischen Erfahrungen, sondern leistet auch einen wichtigen gesellschaftlichen Beitrag. In Marburg-Biedenkopf und Umgebung gibt es eine Vielzahl an anerkannten Trägern, die unterschiedlichste Einsatzstellen anbieten. Im Folgenden stellen wir einige der regionalen Anbieter und deren Einsatzmöglichkeiten vor.
DRK Rettungsdienst Mittelhessen Der DRK Rettungsdienst Mittelhessen bietet rund 50 FSJ- und BFD-Plätze an, insbesondere im Bereich des Rettungsdienstes. Die Einsatzorte verteilen sich auf mehrere Landkreise: MarburgBiedenkopf, Gießen, Frankenberg, Lahn-Dill und Vogelsberg. Freiwillige erleben hier hautnah den Alltag im Rettungsdienst und wirken in einem engagierten Team mit. In Marburg selbst stehen auch unterstützende Bereiche zur Verfügung – beispielsweise in der Logistik, im Simulationszentrum, im Bildungszentrum oder in der
Werkstatt. Diese Aufgabenbereiche ermöglichen Einblicke hinter die Kulissen einer großen Hilfsorganisation.
www.drk-rettungsdienst.de/home
Diakonie Marburg-Biedenkopf
Die Diakonie Marburg-Biedenkopf ist ein großer sozialer Träger, der zahlreiche Einrichtungen in der Region betreibt. Dort können junge Menschen im FSJ oder BFD unter anderem in der Altenhilfe, Behindertenarbeit oder Kinder- und Jugendhilfe tätig werden. Besonders betont wird hier die persönliche Weiterentwicklung der Freiwilligen: Durch neue Erfahrungen und das Kennenlernen eigener Fähigkeiten und Grenzen erhalten die Teilnehmenden wichtige Impulse für ihre berufliche Orientierung und ihre persönliche Reifung. www.ev-freiwilligendienste-hessen.de
Lebenshilfewerk
Marburg-Biedenkopf e.V.
Das Lebenshilfewerk setzt sich für Menschen mit Behinderungen ein und bietet zahlreiche Einsatzmöglichkeiten in den Bereichen Arbeit, Wohnen, Familie, Bildung und Kultur. Die Freiwilligen unterstützen dabei die Teilhabe von Menschen mit Beeinträchtigungen am gesellschaftlichen Leben. Ob in Werkstätten, Wohngruppen oder Freizeitangeboten – die Aufgaben sind vielfältig und sinnstiftend. www.lebenshilfe-hessen.de

Internationaler Bund (IB) –Freiwilligenagentur Marburg Der Internationale Bund (IB) vermittelt FSJ- und BFD-Stellen in mehreren Landkreisen, darunter Marburg-Biedenkopf, Gießen, Vogelsberg und Lahn-Dill. Die Einsatzstellen reichen von Schulen und Kindertagesstätten über Einrichtungen der Jugend- und Kulturarbeit bis hin zu psychiatrischen Einrichtungen und Krankenhäusern. Auch in der Altenpflege sowie in Servicebereichen wie Essensausgabe oder Lagerlogistik sind Einsätze möglich. Die große Bandbreite der Einsatzmöglichkeiten erlaubt es, individuelle Interessen und Fähigkeiten gezielt einzubringen. www.ib-freiwilligendienste.de
Volunta – Beratungscenter Marburg-Biedenkopf Volunta, eine Tochtergesellschaft des Deutschen Roten Kreuzes, bietet eine umfassende Beratung zu FSJ, BFD und auch zum Freiwilligen Ökologischen Jahr (FÖJ). Besonders hervorzuheben ist das breite Spektrum an Einsatzfeldern, das vom sozialen Bereich bis hin zu Bildung und Umwelt reicht. Die persönliche Begleitung während des Dienstes sowie Seminare zur Reflexion und Weiterbildung sind zentrale Bestandteile des Angebots. www.volunta.de/fsj-bfd
FSJ Kultur im Landkreis Marburg-Biedenkopf Für kulturinteressierte junge Menschen bietet das FSJ Kultur des Kreises spannende Einsatzstellen in Theatern, Museen, Musikschulen, Bibliotheken oder kulturellen Jugendprojekten. Träger ist die Landesvereinigung für Kulturelle Bildung Hessen (LKB Hessen). Die Freiwilligen arbeiten meist zwölf Monate lang in einer Kultureinrichtung und erhalten dabei 30 Tage Urlaub und 25 Bildungstage. Das FSJ Kultur ist besonders geeignet für kreative Köpfe, die sich für Kunst, Musik oder Theater begeistern. www.marburg-biedenkopf.de/ bildung_und_freizeit/kultur/fsjkultur.php
ASB Mittelhessen
Der Arbeiter-Samariter-Bund (ASB) bietet vielfältige Möglichkeiten für ein FSJ oder einen BFD. Freiwillige unterstützen zum Bei-
spiel in Kitas oder Schulen, begleiten ältere Menschen in Tagespflegen oder sind im Rettungsdienst tätig. Auch die Organisation und Durchführung von Erste-HilfeKursen gehört zum Spektrum der möglichen Aufgaben. Die Tätigkeiten sind praxisnah, abwechslungsreich und ermöglichen eine enge Zusammenarbeit mit hauptamtlichen Mitarbeitenden. www.asb-mittelhessen.de
Deutsche Blindenstudienanstalt e.V. (blista)
Die Deutsche Blindenstudienanstalt e.V. – kurz blista – ist eine bundesweit bekannte Einrichtung für blinde und sehbehinderte Menschen. In Marburg bietet sie FSJund BFD-Stellen in Bereichen wie schulische Unterstützung, Freizeitgestaltung, Internatsleben oder technischen Hilfsmitteln an. Freiwillige haben hier die Möglichkeit, einen wertvollen Beitrag zur Inklusion zu leisten und die Lebenswelt von Menschen mit Sehbehinderungen kennenzulernen. www.blista.de
Freiwilligenagentur Marburg-Biedenkopf
Die Freiwilligenagentur MarburgBiedenkopf fungiert als zentrale Anlaufstelle für alle, die sich freiwillig engagieren möchten. Neben individueller Beratung informiert sie über die vielfältigen Angebote der verschiedenen Träger und unterstützt bei der Suche nach einer passenden Einsatzstelle. Die Agentur kooperiert mit vielen regionalen Einrichtungen und hilft dabei, Interessen und Einsatzorte bestmöglich abzustimmen. www.freiwilligenagentur-marburg.de
Wer Interesse an einem FSJ oder BFD hat, kann sich direkt über die genannten Websites informieren oder Kontakt mit den jeweiligen Trägern aufnehmen. Viele Organisationen bieten unkomplizierte Online-Bewerbungsverfahren an und stehen auch für persönliche Beratungsgespräche zur Verfügung. Ob als Orientierungsjahr nach der Schule, zur Überbrückung, zur Neuorientierung oder als sinnvolle Lebensetappe – ein Freiwilligendienst bereichert nicht nur den Lebenslauf, sondern auch die eigene Perspektive.
pe/red
Das Freiwillige Soziale Jahr (FSJ) international bietet jungen Menschen die Möglichkeit, sich für einen begrenzten Zeitraum in sozialen, kulturellen oder ökologischen Projekten im Ausland zu engagieren. Dabei steht nicht nur die praktische Mithilfe vor Ort im Vordergrund, sondern auch der interkulturelle Austausch und das persönliche Lernen in einem neuen gesellschaftlichen Kontext.
Das internationale FSJ ist Teil einer Reihe von Freiwilligendiensten, die unter anderem vom Bundesministerium für wirtschaftliche Zusammenarbeit und Entwicklung (BMZ) sowie dem Auswärtigen Amt gefördert werden. Bekannte Programme in diesem Bereich sind etwa „weltwärts“, „kulturweit“ oder das Internationale Jugendfreiwilligenprogramm (IJFD). Die Entsendung erfolgt über anerkannte Trägerorganisationen, die die Freiwilligen während des gesamten Einsatzes begleiten.
Einsatzorte liegen in zahlreichen Ländern weltweit, insbesondere in Afrika, Lateinamerika, Asien und Osteuropa. Die Einsatzstellen variieren stark: Häufig unterstützen Freiwillige Schulen, Kindergärten, Gesundheitsstationen, Behinderteneinrichtungen oder Umweltinitiativen. Auch kulturelle Projekte, etwa in Museen oder Jugendzentren, sind Teil des Programms.
Zugangsvoraussetzungen und Rahmenbedingungen Grundsätzlich richtet sich das FSJ international an junge Menschen zwischen 18 und 27 Jahren. Vorausgesetzt wird meist ein Schulabschluss sowie eine hohe Motivation, sich freiwillig und gesellschaftlich zu engagieren. Vorkenntnisse oder spezielle Qualifikationen sind in der Regel nicht zwingend erforderlich, werden jedoch je nach Einsatzstelle unterschiedlich gewichtet.
Die Dauer des Dienstes beträgt in der Regel zwischen sechs und zwölf Monaten. Vor der Ausreise durchlaufen die Freiwilligen eine vorbereitende Schulung, in der Themen wie interkulturelle Kommunikation, Sicherheit, Entwicklungspolitik oder auch praktische Fragen des Alltags im Gastland behandelt werden. Während des Aufenthalts stehen Begleitseminare sowie Ansprechpartner der Trägerorganisation zur Verfügung. Nach Rückkehr findet in der Regel ein Nachbereitungsseminar statt.
Finanziell ist das FSJ international durch Förderprogramme weitgehend abgesichert. Unterkunft, Ver-

pflegung, Reisekosten und Versicherungen werden in der Regel übernommen, zudem erhalten die Freiwilligen ein Taschengeld. In einigen Fällen ist ein Eigenanteil oder eine Spendenakquise durch die Teilnehmenden vorgesehen, je nach Trägerorganisation.
Bildung, Austausch und persönliche Entwicklung
Ziel des internationalen Freiwilligendienstes ist neben der praktischen Hilfe auch die Förderung von globalem Lernen und interkultureller Kompetenz. Die Erfahrungen im Gastland sollen zu einer bewussteren Auseinandersetzung mit gesellschaftlichen Strukturen, kulturellen Unterschieden und globalen Zusammenhängen beitragen. Dabei steht der partnerschaftliche Aus-
tausch im Mittelpunkt. Die Freiwilligen sollen keine Expertrolle einnehmen, sondern in bestehenden Strukturen mitarbeiten und dabei selbst lernen. Viele Teilnehmer berichten im Nachhinein von einer tiefgreifenden persönlichen Entwicklung. Aspekte wie Selbstständigkeit, Flexibilität und ein erweitertes Weltverständnis werden häufig als prägend beschrieben. Gleichzeitig bleibt der Dienst auch aus Sicht der Gastorganisationen nicht ohne Wirkung: Die Zusammenarbeit mit internationalen Freiwilligen kann den Blick auf eigene Arbeitsprozesse erweitern und neue Impulse setzen.
Bewerbung und Perspektiven Die Bewerbung für ein FSJ im Ausland erfolgt direkt bei den je-
weiligen Trägerorganisationen. Diese bieten Informationen zu den verfügbaren Einsatzstellen, Bewerbungsfristen und spezifischen Voraussetzungen. Da die Nachfrage nach begehrten Projekten mitunter hoch ist, wird eine frühzeitige Bewerbung – in der Regel etwa ein Jahr vor gewünschtem Dienstbeginn – empfohlen. Nach Abschluss des internationalen FSJ eröffnen sich unterschiedliche Perspektiven. Für viele Freiwillige ist das Jahr im Ausland eine Orientierungshilfe für Studium, Ausbildung oder berufliche Laufbahn. Auch im Hinblick auf gesellschaftliches Engagement oder politische Bildungsarbeit kann der Dienst Impulse setzen. Darüber hinaus wird ein absolviertes FSJ international von vielen Hochschulen und Arbeitgebern als wertvolle Zusatzqualifikation gewertet. pe/red
www.weltwaerts.de www.kulturweit.de www.ijfd-info.de


Daniel-Herskedal-Trio am 11. Mai im KFZ
Daniel Herskedal mag die Stille: „Sie ist eine der wichtigsten Zutaten beim Komponieren für mich. In der Stille kann ich mich besser fokussieren, tiefer in mich hineinspüren, meinen Klang finden“, erzählt der norwegische Komponist und Musiker, der fast einen ganz anderen Karriereweg eingeschlagen hätte. Als Jugendlicher war er immerhin kurz davor, die Musik fürs Boxen aufzugeben. Doch dann quittierte der Boxtrainer seinen Dienst, der Boxclub war zu – und Herskedal widmete sich stattdessen der Tuba. Der 1982 in Molde an der norwegischen Westküste geborene Musiker hat es meisterhaft geschafft, in seinen Kompositionen ausgerechnet die Tuba, dieses sonst im Hintergrund benutzte Instrument, in den Mittelpunkt zu stellen. Mit eindrucksvoller Virtuosität lotet er ihre Grenzen aus und erschafft dabei tiefe Klanglandschaften, irgendwo zwischen Jazz und
Klassik, mit vielfältigen weiteren musikalischen Einflüssen und gelegentlich auch elektronisch verfremdet. „The tuba has never sounded this cool“, urteilte die führende Jazz-Plattform „All About Jazz“ knapp. Dabei will Herskedal, der nebenbei auch mit Filmmusik erfolgreich ist, sich nicht auf ein Genre festlegen lassen: „Ich kam irgendwann zu dem Punkt, dass mich der typische Sound der Tuba und meine Rolle als Musiker gelangweilt haben. Dann habe ich begonnen, zu erforschen, was ich noch alles machen kann. Und daran arbeite ich seitdem“, erzählt er nüchtern. Nein, typischer Jazz sei das nicht, schließlich verschmölzen alle Stilrichtungen immer mehr miteinander.
Gerade ist „Movements of Air“ erschienen, das fünfte Album seines Trios mit Eyolf Dale am Klavier und Helge Andreas Norbakken an Schlagzeug und Percussion. Am 11. Mai macht das Trio damit im Mar-
Relaxed Performance im TNT am 2., 3. & 4. Mai
Pünktlich zum Tag der Arbeit präsentiert das TNT seine neueste Produktion „Faulpelz“. In dieser ebenso unterhaltsamen wie tiefgründigen Auseinandersetzung mit den Begriffen Arbeit und Faulheit wagt die Performerin Arnita Jaunsubrēna, scheinbar Selbstverständliches zu hinterfragen. Was genau bedeutet Faulsein in unserer heutigen Leistungsgesellschaft? Wann wird ein Mensch eigentlich als faul abgestempelt? Wo finden wir Platz für
Fehler, Pausen und Veränderungen in der westlichen Arbeitskultur?
Die Performance „Faulpelz“ beschäftigt sich mit der Geschichte der Faulheit, – einer moralischen Einheit, die nur in ihrer Beziehung zur Arbeit sichtbar wird. Faul ist man nicht dann, wenn man was tut, sondern dann, wenn man was nicht tut. In ihrer Solo-Performance setzt sich die Künstlerin Arnita Jaunsubrēna mit ihrer eigenen Produktivität auseinander, die durch eine chronische Erkran-
burger KFZ Station. Im Zentrum des neuen Albums stehen Themen wie Hoffnung und der Wunsch nach einer besseren Zukunft – mit komplexen Kompositionen thematisiert Herskedal das Gleichgewicht zwischen Gut und Böse sowie Krieg und Frieden. Freilich sind die Stücke immer auch eine Gemeinschaftsarbeit: „Ich komponiere nicht für Tuba, Schlagzeug und Piano, ich komponiere für mich, es ist sehr persönlich“, sagt er. „Ich will, dass die anderen sich mit meinen Ideen auseinandersetzen und ihre eigenen im Spiel einbringen.“ Herskedal lebt zusammen mit der renommierten samischen Sängerin Marja Mortensson, von deren traditionellem Joik-Gesang er Elemente in sein Tuba-Spiel übernommen hat. Gerade erst sind sie von Trondheim an der Küste in Norwegens alte Bergbaustadt Røros gezogen, näher zu Mortenssons Familie, die Rentierzucht be-
kung abgenommen hat. Im Format der Lecture Performance konfrontiert sie Aspekte wie Scham und gesellschaftliche Erwartungen. Sie erzählt persönliche Geschichten und untersucht die „Arbeitstiere“ der eigenen Familie, die sie geprägt haben, redet über Schimmel und Kompost und un-
treibt. Die Landschaft um Røros ist geprägt von Bergen, Flüssen, Seen und Mooren – und wird sicher auf die ein oder andere Art in den Kompositionen von Herskedal Einzug halten. Schließlich spielen Landschaften – und der Weg durch diese – fast immer tragende Rollen in seiner Musik. Womit wir zurück zur Stille kommen, die Daniel Herskedal beim Komponieren zu fokussieren hilft: „Wenn ich im Januar durch die eisigen Schneelandschaften gehe und die weiße Decke auf dem Boden jedes Geräusch schluckt. Das ist eine Atmosphäre, die ich liebe, dabei hat man das Gefühl, sich in einem Vakuum zu befinden, – weit weg vom Alltag und offen für die Musik.“
kro
Das Daniel-Herskedal-Trio spielt am Sonntag, 11. Mai, um 20 Uhr im KFZ.
tersucht den Arbeitszwang des Staates. Am Ende findet sie Zuflucht in der Ruhe der Faultiere. pe
Faulpelz 2. & 3. Mai jeweils um 20 Uhr im TNT 4. Mai um 17 Uhr im TNT

• 17qm – Raum für Möglichkeiten
Steinweg 2 Do 16–18, Sa 11–14 Uhr
„Translucide – Mixed Media“ – Arbeiten von Meike Porz. (bis 10.5.)
• Alte Kirche Niederweimar Lindenweg 13 – 35096 Weimar/Lahn 11.5., 25.5., 15.6. 15–17 Uhr oder nach Vereinbarung
„Kreative Experimente“ – Malerei von Peter Jakobi. (bis 15.6.)
• Alte Uni – Fachbereichsbibliothek Theologie Foyer, Lahntor 3 (Eingang Reitweg) Mo–Fr 8–18 Uhr
„Ihren Platz in der Welt finden – Else Niemöller (1890–1961)“. (bis 22.5.)
• Cineplex
Biegenstraße 1a
Zu den Öffnungszeiten des Kinos
„Filmrolle bis Fingertipp: Eine Marburger Geschichte der Kameratechnik“ – Eine Ausstellung zur Geschichte der Kameratechnik mit Exponaten des Kameramuseums Marburg. (bis 19.5.)
• Die Foto Passage Elwert-Passage, Reitgasse Tägl. 6–1 Uhr
„Stadt.Teil.Ansichten“ – Fotografien von Mitgliedern der FotoCommunityMarburg & des KulturNetzwerkFotografieMarburg.
• Dorfarchiv Bauerbach Kirchweg 4, MR-Bauerbach Sa 15–18 und nach Vereinbarung „Japan-Impressionen“ – Fotografien von Jana Dostal. (bis 27.9.)
• Dorfmuseum Oberrosphe Im Rosphetal 8, 35083 Wetter-Oberrosphe Sa/So 14–17.30 Uhr Über 100 Teddybären aus der Sammlung von Jochen Schäfer, liebevoll arrangiert in Alltagsszenen. (bis Ende Juli)
• Galerie für Menschen auf der Straße Gisselberger Straße 35 geöffnet nach Vereinbarung: jens.schneider@ekkw.de „Der südkoreanische Blick auf Deutschland“ – Fotografien von Studierenden aus Südkorea in Deutschland aus der Zeit von 1980 bis 2000. (bis 5.9.)
• Galerie Haspelstraße eins Haspelstraße 1 Di–Fr 15–18 sowie Sa 13–15 Uhr Heidrun Schultz: „Aus dem Rahmen Gefallenes“ – Arbeiten aus Acryl auf Papier. (bis 3.5.)
• Gemeindeverwaltung Lohra Heinrich-Naumann-Weg 2, 35102 Lohra
Mo–Do 8.30–12, Di 14–17, Do 15–18 Uhr, Fr nach Terminvereinbarung „tierisch-tierisch“ – Eine Gemeinschaftsausstellung von bildsymphonie.de & friends. (bis 30.9.)
• Hessisches Landestheater Marburg Am Schwanhof 68–72
Zu den Öffnungszeiten des Theaters „Migrantischer Widerstand der 90er Jahre“ – eine Wanderausstellung über Anlässe und Formen von selbstorganisiertem Widerstand von Migrant*innen, Geflüchteten und Jugendlichen in den 90er Jahren. (bis 15.5.)
• Hinterlandmuseum Schloss Biedenkopf Zum Landgrafenschloss 1, 35216 Biedenkopf Di–So 10–18 Uhr
„Schwein gehabt“ – Arbeiten zu den Ursprüngen und Hintergründen von Redewendungen. (bis 6.7.)
• Heimatmuseum Garbenheim Untergasse 3, 35583 Wetzlar-Garbenheim jeden 1. So im Monat 15–17 Uhr „Werther und Wahlheim“ – Zu Garbenheim und der Natur. (bis 31.8.)
• Herder-Institut Gisonenweg 5–7
Mo–Fr 8–16 Uhr
„Das alte Dorpat 1889. Tartu in Fotografien des Ateliers Carl Schulz“. (bis 9.5.)
• Kameramuseum Marburg
Am Grün 44 So 14–18 Uhr. Tel.: 06421/12170, E-Mail: guenter@giesenfeld.de
Etwa 250 Kameras aus der Sammlung Giesenfeld, Zubehörteile, Projektoren, historische Filmvorführungen u.v.m.
• KA.RE
Biegenstraße 30 Tägl. (außer Mi) 11.30–22 Uhr
„Metamorphosis“ – Fotografien von C. A. Barnikol.
• KiZ (Kultur im Zentrum) Gießen
Südanlage 3a, 35390 Gießen
Di–So 10–17 Uhr
„Was macht die Kunst?“ – Studierende des Instituts für Kunstpädagogik der JLU Gießen zeigen ihre Abschlussarbeiten. (bis 1.6.)
• Landgrafenschloss Marburg
Di–So 10–18 Uhr
„Minerale – Schätze der Erde zu Gast im Landgrafenschloss“. (bis 31.7.26)
• Leica Galerie Wetzlar
Am Leitz-Park 5, 35578 Wetzlar
Tägl. 10–18 Uhr
„70 Jahre Leica M“ – ikonische Bilder und historische Leica-M-Modelle. (bis 1.6.)
„Das gute Bild“ – Einblick in die FotografieSammlung des Leica Archivs. (bis 1.6.)
„100 Porträts – Gesichter hinter der Kamera“ – Ein Stück Leica-Geschichte. (bis 21.12.)
• Marburger Kunstverein
Gerhard-Jahn-Platz 5
Di–So 11–17, Mi 11–20 Uhr
„we should never say that we drifted far“ – Arbeiten von Benjamin Tiberius Adler und Daniel Hörner. (bis 18.6.)
• Neuer Kunstverein Gießen e.V. Ecke Licher Str./Nahrungsberg Samstags 15–18 Uhr
„Nach Strich und Faden“ – Arbeiten aus Draht, Stoffresten und Perlen von Kerstin Johanna Kästner. (bis 10.5.). Artist Talk: 10.5., 16 Uhr.
• Neues Rathaus Wetzlar
Ernst-Leitz-Straße 30, 35578 Wetzlar Zu den Öffnungszeiten des Rathauses „Werk, Mitarbeitende, Produktion“ – Einblicke in die Geschichte der Leica-Manufaktur. (bis 31.7.)
• Oberhessisches Diakoniezentrum Schottener Straße 4, 35321 Laubach zu den Öffnungszeiten des Zentrums „Crossover – Kunst im Wandel von Licht und Zeit“ – Fotos von bildsymphonie.de/ Karlheinz Schuhmacher. (bis 7.9.)
• Psychiatriemuseum Gießen
Licher Straße 106, Haus 10, UG Jeden 1. Samstag im Monat 14–17 Uhr „Vom Wert des Menschen“ – Werke über die Geschichte der Gießener Heil- und Pflegeanstalt 1911–1945. (bis Ende 2025)
• Rathaus Marburg Historischer Rathaussaal, Am Markt 1 Mo–Mi 7–16, Do 7–18, Fr 7–12.30 Uhr „Rosa Winkel. Als homosexuell verfolgte Häftlinge in den KZ Buchenwald und Mittelbau-Dora“. Eine Ausstellung von Studierenden der Friedrich-Schiller-Universität Jena in Zusammenarbeit mit der Stiftung Gedenkstätten Buchenwald und Mittelbau Dora. (bis 7.5.)
• Restaurant Kaufhaus Ahrens Universitätsstraße 14–22 Mo–Fr 9–19 Uhr und Sa 9–18 Uhr „Gesichter“ – Arbeiten von Mitgliedern der FotoCommunityMarburg. (bis Ende Mai)
• Ristorante & Pizzeria Colosseo Deutschhausstraße 35 Di–So 11.30–14.30 & 17.30–23 Uhr „Geographische Inspirationen – Ein Geograph sieht Italien“ – Arbeiten von Walter Wilhelm Jungmann. (bis Ende Juni)
• Rotkehlchen in der Waggonhalle Rudolf-Bultmann-Str. 2a Mi–Sa ab 18, So ab 10.30 Uhr „Der bewegte Mensch“ – Arbeiten von Yasemin Skrezka. (bis 11.5.)
• Stadtbibliothek Wetzlar Bahnhofstraße 6, 35576 Wetzlar Di–So und an Feiertagen 11–16 Uhr
Malerei und Lyrik von Lore Wellstein und Michael Krause-Blassl. (bis 25.5.)
• Stadtbücherei Marburg
Ketzerbach 1 Di/Do/Fr 12–18.30, Mi/Sa 10–14 Uhr „Stadt.Kultur.Geschichte“ – Städtefotografie von Stefan Aumann. (bis 31.5.)
• Stadtwerke Marburg
Am Krekel 55
Mo–Do 8–16.30, Fr 8–15.30 Uhr „Naturraum Region Marburg“ – Arbeiten aus dem Fotowettbewerb der Stadtwerke Marburg.
• Tobis Bistro & Restaurant Bahnhofstraße 15, Lohra Di–Sa 17–22, So 12–14 und 17–22 Uhr „Schwarzlichtfotografie – Verborgene Dimensionen der Realität“ – Ergebnisse eines Fotoworkshops von Karlheinz Schuhmacher.
• TTZ – Technologie- & Tagungszentrum Softwarecenter 3 Mo–Fr 8–17 Uhr „Der Mensch im Raum – Linien, Flächen und Strukturen“ – Fotografien von Thomas Dimroth. (bis 30.9.)
• Universitätskirche Marburg Reitgasse Tägl. 9–19 Uhr „Neue Erzählungen“ – Fotografien von gleis3eck (Volker Jansen, Alfred Junker und Martin Lüpkes). (bis 18.5.)
• UKGM (Standort Gießen) Hauptgebäude, Klinikstraße 33, Gießen Zu den Öffnungszeiten des Klinikums „Farbe, und dann.“ – Arbeiten von Katja Eminusk, Andreas Rück und Volker Schönhals. (bis 3.10.)
• UKGM (Standort Marburg) Baldingerstraße, Hauptgebäude, Eingangshalle Ebene -1 zu den Öffnungs- und Besuchszeiten „Gedankenräume“ – Fotografien von Martin C. Hirsch. Den Schwerpunkt bilden abstrakte sowie hyperrealistische Stillleben. (bis 31.7.)
• Untere Stadtkirche Wetzlar Schillerplatz, 35578 Wetzlar Zu den Öffnungszeiten der Stadtkirche „Unterwegs“ – Jahresausstellung der Fotofreunde Wetzlar. (bis 9.6.)
• Weltladen & Café Fair Marktstraße 11, 35075 Gladenbach Weltladen: Mo–Fr 10–18 Uhr, Sa 10–13 Uhr Café Fair: Mi–Sa 14–18 Uhr Fotografien zum Thema „Fairer Handel goes Klimagerechtigkeit“.

„Was macht die Kunst?“




M U S I K
Fred Hills Trio
Jazz & Indie
Fr 2.5. 21 Uhr, Q
Die Musik von Fred Hills ist eine Mischung aus zeitgenössischem Jazz, Alt-Folk und progressivem Indie und lässt sich von einer breiten Palette von Genres inspirieren. Er ist stark von außergewöhnlichen Klängen geprägt und schafft Kompositionen, indem er Einflüsse aus der ganzen Welt der Musik miteinander verschmilzt. Inspiriert von einzigartigen und revolutionären Musikern, lässt Fred Hills seine Liebe zu Jazz, Prog, Electronica, Welt- und Folkmusik in seine farbenfrohen Rhythmen, melodischen „open handed“ Beats und delikaten gitarrenbasierten Kompositionen einfließen.
Rosalie Cunningham
„To Shoot Another Day”
Support: Amy Montgomery
Sa 3.5. 20.30 Uhr, KFZ
Die mehrfach preisgekrönte Sängerin, Songwriterin und Multiinstrumentalistin Rosalie Cunningham veröffentlichte 2019 ihr für den Mercury Music Prize nominiertes, selbst betiteltes Debütalbum und wurde von der Kritik hoch gelobt. Seitdem baut sie ihren Ruf als originelle und zum Nachdenken anregende Songwriterin und Musikerin weiter aus und hat im Herbst 2024 ihr drittes Album „To Shoot Another Day“ veröffentlicht, mit dem sie im bekannten WDR-„Rockpalast“ ausgetreten ist und nun auch nach Marburg kommt.
Inga Saalmann Quintett
„An Evening With Anita O’Day“ Konzert & Lesung
Sa 3.5. 20 Uhr, Waggonhalle
Anita O’Day war neben Ella Fitzgerald und Billy Holiday eine der größten Jazz-Sängerinnen des letzten Jahrhunderts und besonders für ihr Timing und ihr Improvisationstalent bekannt. Selbst bezeichnete sie sich als Songstylistin. Aus ihrem abwechslungsreichen Repertoire präsentiert das Inga Saalmann Quintett unterschiedliche Songs, darunter die Version von Sweet Georgia Brown, die sie auf dem Newport Jazz Festival 1958 sang.
Inga Saalmann hat es sich als versierte Jazzsängerin für diesen Abend zur Aufgabe gemacht, nicht nur mit Songinterpretationen an Anita zu erinnern, sondern auch mit Hilfe ihrer Autobiographie „High Times, Hard Times“ aus ihrem Leben zu berichten, das von unglücklichen Ehen, Heroinabhängigkeit und wechselhaftem musikalischem Erfolg gekennzeichnet war.
Martin P. Koob, in Gießen als künstlerischer Leiter des KellerTheatre kein Unbekannter, wird Text und Zitate vortragen.
Airboxes
Akkordeon-Doppel-Power
So 4.5. 20 Uhr, KFZ
Airboxes hauchen der BalFolkSzene auf ihren Akkordeons neues Leben ein. Der eine mit verspielten Verzierungen auf seinem chromatischen Modell, der andere mit den warmen Bordunklängen des diatonischen Akkordeons. Bekannt für ihre hypnotisierende Mischung aus traditionellen und modernen Stilen, weben die Musiker komplizierte Melodien und Harmonien, die in das Herz des BalFolk-Genres entführen. Ihre energiegeladenen Auftritte schaffen eine lebhafte Atmosphäre, die perfekt zum Tanzen ist.

Frank’s White Canvas
Mi 7.5. 21 Uhr, Q
Frank’s White Canvas ist ein Duo aus Chile, das mittlerweile seinen Wohnsitz in Berlin hat. Die beiden Musikerinnen wollen Menschen Hoffnung geben und in ihren persönlichen Kämpfen begleiten. In ihrer kurzen Karriere sind die beiden bereits auf Bühnen wie dem Mad Cool Festival in Spanien, Vive Latino in Mexiko-Stadt, Rock al Parque in Kolumbien und Lollapalooza in Chile aufgetreten. Im Jahr 2022 eröffnen sie die Show für Guns N’ Roses in Chile. Darüber hinaus hat das Duo seine Musik auf Tourneen in den USA, Europa und Südamerika vorgestellt.
Gregor Meyle „Wohnzimmerkonzerte 2025“ Do 8.5. 20 Uhr, Erwin-Piscator-Haus Es ist das erste Mal seit vielen Jahren, dass Gregor Meyle in kleinerer Besetzung auf eine Tournee durch ausgewählte Locations geht. Er wird mit einer handvoll Musiker seiner Band begleitet, aber es wird etwas ruhiger, nachdenklicher und gemütlicher. Das bedeutet mehr Freiraum für die Songs, die der Songpoet mit Hut, Brille und Gitarre zumeist allein schreibt und sie so auf seine ganz eigene Art und Weise präsentieren kann.
Colosseum „Out Into The Fields“
Do 8.5. 20.30 Uhr, KFZ
Der Name klingt bombastisch, und tatsächlich sind Colosseum so etwas wie Saurier in der Geschichte der Rockmusik: ein Zusammenschluss von virtuosen Solisten, dabei trotzdem mit einem geschlossenen, kompakten Sound und in den verschiedenen Konstellationen musikalisch sehr innovativ. Das Doppelalbum „Colosseum Live“ kann sicherlich auch heute noch getrost als ein Juwel in der Geschichte der Rockgeschichte
bezeichnet werden. 2025 setzt sich die Band zur Freude zahlreicher Fans wieder in Bewegung. Unter dem Motto „The Return Of The Legend“ präsentieren die Originals Chris Farlowe, Clem Clempson & Mark Clarke neben Colosseum-Klassikern wie „Lost Angeles“ und der „Valentyne Suite“ auch Songs ihres aktuellen Studioalbums „Restoration“.
Cindy aus Marzahn „Einmal Prinzessin und zurück“ Fr 2.5. 20 Uhr, Buderus Arena Wetzlar 20 Jahre Cindy aus Marzahn - Die Jubiläums-Tour wird 2025 fortgesetzt und jetzt wird die ganze Republik in pink getaucht. Nachdem sich die Kultfigur Cindy aus Marzahn 2016 von der großen Bühne verabschiedet hatte, kehrte sie 2024 anlässlich ihres 20-jährigen Bühnenjubiläums zurück. Und so fegt die amtierende Miss Leberwurst auch durch Wetzlar und amüsiert mit herzhaften Stories aus dem Leben eines Sexsymbols gefangen im Körper eines LKWFahrers. Eine Show voller Herz und großer Gefühlen, aber vor allem mit jeder Menge Spaß.
Theater GegenStand „Sprache ist eine Waffe. Haltet sie scharf.“
Ein Kurt Tucholsky Abend Fr 2.5. 20 Uhr, Waggonhalle Ein Abend über Kurt Tucholsky, Autor, Journalist, einer der schärfsten Kritiker der bestehenden Verhältnisse seiner Zeit. Mit scharfem Geist und bösem Witz kommentierte er Politik und Gesellschaft. Gleichzeitig war er erfolgreicher Couplet- und Chansonschreiber, seine Fähigkeit, eine Abendgesellschaft aus dem Stehgreif zu unterhalten, war legendär. Das Programm ist ein Potpourri aus dem Gesamtwerk des Meisters

der scharfen Feder, dessen Bandbreite vom frivolen Chanson und heiteren Liebesroman über den zeitlosen Aphorismus hin zum scharfen Leitartikel reicht. Inga Berlin und Stefan Delanoff bringen Texte, Lieder und Gedichte modern interpretiert wieder zum Vorschein. Ein kleiner, unterhaltsamer Blick in die Zeit der Weimarer Republik, komisch, bissig, schonungslos – und überraschend aktuell.
Quichotte
„Alles echt“
Comedy
Fr 2.5. 20 Uhr, KFZ
Ein Sprichwort besagt, der Scherz sei das Loch, aus dem die Wahrheit pfeift. Und Quichotte setzt schonmal feixend sein Teekännchen auf, in der Hoffnung, es pfeife bald, was das Zeug hält. Denn wenn es ein Gut gibt, das in vielerlei Hinsicht unter die Räder kommt, so ist das doch die Wahrheit. Genug davon, findet er, und legt die aufgehübschte Maske der gekünstelten Geselligkeit ab. Mit neuen Songs und Geschichten im Gepäck und in bester FreestyleLaune zieht Quichotte los, um die Fakeness das Fürchten zu lehren. Zu Hilfe kommt ihm dabei sein Lieblingsbäcker, der ohnehin kein Blatt vor den Mund nimmt.
Theater GegenStand
„Frau Holle“
Märchen für Kinder ab 3 Jahre So 4.5. 15 Uhr, Waggonhalle
In die Welt von Frau Holle, die Brunnenwelt, die sich aber gleichzeitig auch über den Wolken befindet, geraten zwei Stiefschwestern, wie sie unterschiedlicher nicht sein könnten: Während die eine ihrem Wesen gemäß stets hilfsbereit und verantwortungsvoll handelt, denkt die andere nur an sich selbst. Frau Holle hat für jede den passenden Lohn ... Liebevoll und lustig nach den Brüdern Grimm in Szene gesetzt von Theater GegenStand.
Marburger Science Slam Wissenschaft trifft Entertainment Di 6.5. 20 Uhr, Waggonhalle
Beim Science Slam verlassen Forscher unterschiedlichster Disziplinen ihre Labore und erobern die Bühne. Kreativ, informativ und voller Leidenschaft. In kurzweiligen, spannenden Vorträgen präsentieren sie ihre Arbeit auf unterhaltsame und publikumsnahe Weise und kämpfen um die Gunst des Publikums. Alles ist erlaubt, solange es fesselt, und das Publikum entscheidet in einem lebhaften Abstimmungsprozess, welcher Beitrag die beste Kombination aus Wissenschaft und Unterhaltung bietet.
Der Marburger Science Slam wird organisiert und moderiert von Bernd Waldeck (Wissenskabarettist) und Martin Esters (Improschauspieler). Interessierte Slammer für weitere Termine können sich melden unter: info@berndwaldeck.de
Waggonhalle & Werkraum56 „Vinter“ von Jon Fosse ab Do 8.5. 20 Uhr, Waggonhalle In einer fremden Stadt kreuzen sich die Wege zweier Menschen. Ein flüchtiger Moment wird zum Wendepunkt, und aus einer zufälligen Begegnung erwächst eine Leidenschaft, die das Leben aus den Angeln hebt. LiteraturnobelpreisträgerJon Fosse entführt in eine Welt, in der das Gewohnte plötzlich fremd und das Unmögliche verführerisch wird. In der multimedialen Inszenierung von Steffen Schmidt verschmelzen klassisches Erzähltheater mit einem filmischen Soundtrack und Video zu einem intensiven Erlebnis über Verlangen, Verlust und den schmalen Grat zwischen Halt und Haltlosigkeit.




NEU: Thunderbolts
Ab 12 J., tägl. 17.15 + 20.30*(*So 20.15), Fr + Sa 22.45
3D: tägl. 16.45 + 20.00
3D OV: So 20.30
OV: Do 20.15
NEU:
Bambi – Eine Lebensgeschichte aus dem Walde
Ab 0 J., Do – Sa 14.30, So 12.15 + 14.30
NEU: Die Legende von Ochi
Ab 6 J., Do – So 14.45 + 17.30, Mo – Mi 17.30
The Accountant 2
Ab 16 J., Do – So + Di 19.30, Mo + Mi 19.45
Until Dawn
Ab 16 J., Do + Mo – Mi 20.30, Fr + Sa 20.30 + 23.00, So 17.45 + 20.30
Blood & Sinners
Ab 16 J., tägl. 19.45, Fr + Sa 22.30
Drop – Tödliches Date
Ab 12 J., Fr + Sa 23.00
Warfare
Ab 16 J., Fr + Sa 23.00
Moon, der Panda
Ab 6 J., So 12.30
The Amateur
Ab 12 J., Do – Sa + Mo – Mi 20.15
OV: So 20.15
Ein Minecraft Film
Ab 12 J., 2D: Do + So 14.30 + 17.15, Fr + Sa 14.30, 17.15 + 20.15, Mo + Mi 17.15 + 20.15, Di 20.15
3D: Do – Sa 15.00 + 17.45, So 15.00, Mo – Mi 17.45
Schneewittchen
Ab 0 J., tägl. 17.30
Ein Mädchen namens Willow
Ab 0 J., Do – So 15.00
Wunderschöner
Ab 12 J., So 16.15, Mo 16.45
Paddington in Peru
Ab 0 J., Do – So 15.00
Die drei ??? und der Karpatenhund
Ab 6 J., Do – Sa 17.00
SPECIALS
Sneak des guten Geschmacks Fr 23.00
Grüße vom Mars
OP-Vorpremiere + Family Preview
Ab 6 J., So 14.00
Gost in the Shell 2: Innocence
Ab 12 J., OmU: Di 20.00
Sneak Preview Di 22.30 OV Di 22.30

NEU: Klandestin
Ab 12 J., Sa + Mo 19.45, So 19.30, Di + Mi 17.30
Der Pinguin meines Lebens
Ab 6 J., Do – Di 17.15 + 20.00, Mi 17.15
Mein Weg – 780 km zu mir
Ab 12 J., Do – Sa 17.30
Oslo-Stories: Liebe
Ab 12 J., So 19.45
Ich will alles. Hildegard Knef
Ab 12 J., Do + Fr 14.45, Sa + So 17.00
Flow
Ab 6 J., Sa – Di 17.45
Heldin
Ab 6 J., Fr + Di 17.00, Sa – Mo 20.15
Konklave
Ab 6 J., Do 20.00, Fr + Sa 19.30
Ein Tag ohne Frauen
Ab 0 J., So + Mo 17.45
Voilá, Papa! – Der fast perfekte Schwiegersohn
Ab 12 J., Do + Fr 20.15
Der Wald in mir
Ab 12 J., Di 20.15, Mi 17.00
Alles außer gewöhnlich
Ab 16 J., Mo 18.30
Mufasa – Der König der Löwen
Ab 6 J., Sa + So 15.00
Lars is Lol
Ab 6 J., Do + Fr 15.00, Sa + So 15.15
SPECIALS
Woodwalkers Filmhits für KinoKids
Ab 0 J., Do – So 14.30
Papst Franziskus – Ein Mann seines Wortes
Ab 0 J., So 14.45
Red Heat
Best of Cinema
Ab 18 J., Di 20.00
Für immer hier
Cine Art – die Filmkunstreihe
Ab 12 J., Do 17.00, Sa 14.30, Mi 19.30
Parthenope
Ab 16 J., Mi 19.45
Einfach machen! She-Punks von 1977 bis heute Ab 6 J., Di 19.30, Mi 20.15
MARBURGER KAMERAPREIS 2025:
Sobibor, 14. Oktober 1943, 16 Uhr Do 10.00
Von Menschen und Göttern
OmeU: Do 14.30
Eine ganze Nacht
OmeU: Do 21.00
Ponette OmeU: Fr 10.00
Annette OmU: Fr 14.00
The Innocents
OmeU: Fr 18.15
Irrtümer und Änderungen vorbehalten.
Ticketverkauf online über www.cineplex.de/marburg oder an den Kinokassen im Cineplex und Capitol.


„Mein Weg – 780 km zu mir“ von Bill Bennett
Wie ist Bill Bennett auf diese Idee gekommen, den Jakobsweg zu gehen? Sein Kniegelenk ist nach einem Sturz kaputt, seine Frau daheim in Australien sorgt sich sehr, und bei den Leuten, die mit Bill pilgern, eckt er immer wieder mit seiner schroffen, allzu direkten Art an. Und es sind noch über 700 Kilometer bis Santiago de Compostela ... Der australische Produzent, Drehbuchautor und Regisseur Bill Bennett ist nicht besonders spirituell veranlagt, doch als er bei einem Spanienurlaub zufällig auf eine Gruppe von Pilgern trifft, lässt ihn die Begegnung nicht mehr los. Er fasst den Entschluss, selbst den Jakobsweg nach Santiago de Compostela zu gehen. Je weiter Bill den beschwerlichen Weg geht, desto mehr Menschen begegnen ihm, die sich ihm gegenüber öffnen und ihre Geschichten erzählen. So unterschiedlich diese sind: Sie alle nehmen ihn, den grummeligen älteren Mann, so wie er ist. Ihm wird klar: Er darf keinesfalls aufgeben. Denn wenn er es bis zum Ziel schafft, wird er ein anderer Mensch sein. Die 31 Tage auf der Pilgerroute verändern sein Leben – Schritt für Schritt. Am Ende des Weges ist Bill Bennett nicht mehr derselbe: der Jakobsweg und die Begegnungen mit den Menschen haben ihn tiefgreifend verändert.
„Eigentlich wollte ich diesen Film gar nicht drehen“, verrät der Filmemacher. „Ich wollte keinen Film machen, in dem es um mich selbst geht, um meine Fehler und Unzulänglichkeiten, und um die Nöte, die mich bis an den Rand des Abgrunds brachten.“ Schließlich entschied er sich doch dafür, es zu versuchen. „Dann aber stellte sich mir sofort die Frage; Wie schaffe ich es, einen Film über den Jakobsweg zu machen, der die echte
Erfahrung transportiert?“ Der einzige Weg für ihn, seine Geschichte wahrhaftig zu erzählen, war, mit einem möglichst kleinen Team zu drehen und dabei die echten Pilger dazuzuholen.
„Mit der Mini-Crew war es uns möglich, innerhalb des ständigen Flusses der Pilger zu arbeiten. Wir waren sehr beweglich und wurden praktisch unsichtbar. Das erlaubte uns, den wahren Camino einzufangen.“
Der Stil des Films, der Schnitt, der Tonfall, der Aufbau der Szenen, die Frage, welches Filmmaterial zu verwenden wäre – Alles sollte dazu dienen, die Erfahrung des Jakobswegs authentisch einzufangen.
„Am Ende der Postproduktion habe ich das Gefühl, dass ich mein Ziel erreicht habe – einen wahrhaftigen Film über einen Mann zu drehen, der einen grundlegenden Wandel seines Charakters und seiner Weltsicht durchmacht, indem er den Jakobsweg geht.“
Der Jakobsweg ist ein ganzes Netzwerk von Pilgerwegen, die zum Grab des Heiligen Jakobus in Santiago de Compostela im Nordwesten Spaniens führen. Die lange Pilgerreise, ursprünglich eine rein religiöse Wallfahrt, ist für viele der heutigen Pilger vor allem eine spirituelle Erfahrung. Schätzungsweise sechs Millionen Menschen gehen jährlich den Jakobsweg oder zumindest Teile davon. Australien, Bill Bennetts Heimatland, gehört zu den Top Ten der Herkunftsländer ausländischer Pilger. 2022, 2023 und 2024 wurden jeweils neue Rekordzahlen an Pilgern erreicht, und es wird erwartet, dass die Zahl in den kommenden Jahren noch weiter steigt. pe/MiA
„Klandestin“
Der mäßig erfolgreiche Künstler Richard (Lambert Wilson), der sich seine britische Heimat nicht mehr leisten kann, lebt in Tanger und bereitet sich auf seine nächste Vernissage in Deutschland vor. Währenddessen träumt der junge Marokkaner Malik (Habib Adda) seit langem von einem besseren Leben in Europa. Als er mit Hilfe von Richard illegal nach Deutschland gelangt, glaubt er sich am Ziel seiner Träume. In Frankfurt soll ihn ausgerechnet Mathilda Marquardt (Barbara Sukowa) verstecken, eine alte Freundin Richards und konservative Politikerin, die für ihre fremdenfeindlichen Positionen bekannt ist. Mathildas Assistentin, die Juristin Amina El Hazzaz (Banafshe Hourmazdi), die ihre marokkanischen Wurzeln endlich hinter sich lassen will, wird als „kulturelle Vermittlerin“ eingeschaltet und soll das Problem lösen. Doch während Mathilda mit ihrer inneren Zerrissenheit kämpft und Richard verzweifelt versucht, Malik für sich zu gewinnen, gerät der Junge immer tiefer in eine Spirale aus unvorhersehbaren Ereignissen. Unwissentlich löst er eine Kette von Entwicklungen aus, deren Konsequenzen für alle Beteiligten folgenschwer sein könnten ...
„Klandestin“ ist ein emotionaler Polit-Thriller, der die Geschichte von Richard, Mathilda, Amina und Malik aus ihren vier einzelnen Perspektiven erzählt. Dabei enthüllt Regisseurin und Drehbuchverfasserin Angelina Maccarone nach und nach die Geheimnisse, Sehnsüchte und Verstrickungen ihrer Figuren, die nicht gegensätzlicher sein könnten. Eines jedoch eint sie alle: die Suche nach Liebe, Zugehörigkeit und einem Platz im Leben. Immer mehr Details werden freigelegt, bis sich alles wie in einem Puzzle zu einem vielschichtigen Gesamtbild fügt.
Der Film zeichnet das Bild der globalisierten Welt, in der scheinbar unverbundene Schicksale auf komplexe Weise miteinander verwoben sind. Vier Protagonisten stehen exemplarisch für die wachsenden Spannungen – auch in Europa.
„In der Begegnung zwischen der konservativen, deutschen Europaabgeordneten Mathilda und dem jungen Marokkaner Malik treten neben der offenkundigen Symbolik altes Europa versus arabischer’ Frühling“ auch die Grautöne zutage“, erläutert Angelina Maccarone: „Es gibt keine klassische Liebesgeschichte und doch geht es um die Liebe. Gerade in ihrer Ab-
„Lars ist LoL“ von Eirik Sæter Stordahl
Am ersten Schultag wird die 11jährige Amanda dazu aufgefordert, ihrem neuen Mitschüler Lars, der am Down-Syndrom leidet, als Mentorin zur Seite zu stehen. Amanda fühlt sich überfordert und fürchtet, dass Lars sie in peinliche Situationen bringen könnte – vor allem, da er schnell zum Ziel von Spott und Mobbing wird. Auch Amanda hat es schwer, sich in ihrer Klasse zu behaupten, und versucht zunächst, Abstand zu Lars zu halten. Doch während sie ihn besser kennenlernt, entdeckt sie seinen Humor, seine Herzlichkeit und seine Stärke. Zwischen den beiden entsteht eine besondere Freundschaft, die Amanda neuen Mut gibt – aber auch ihren eigenen Platz in der Klasse infrage stellt.
Als der Druck ihrer Mitschüler wächst, sich von Lars zu distanzieren, steht Amanda vor einer schwierigen Entscheidung: Gibt sie dem Gruppenzwang nach, oder stellt sie sich offen an Lars’

wesenheit wird sie schmerzlich spürbar.“ Jede der Figuren sehnt sich danach, doch die Beziehungen zwischen ihnen sind stark wirtschaftlich geprägt und zeugen von gegenseitigen Abhängigkeiten. „Liebe wäre der Schlüssel, doch weil die Umstände es ihnen kaum erlauben, dies zu erkennen, und die gegenseitigen Vorurteile ihnen den Blick füreinander verstellen, drohen alle vier zu scheitern“, so die Regisseurin weiter. „Um die Verknüpfung der Charaktere miteinander zu unterstreichen, verlasse ich mit ,Klandestin’ die klassische Dreiaktform zugunsten einer multi-perspektivischen Erzählweise, bei der wir die Geschehnisse jeweils durch die Augen einer anderen Person erleben und daher jedes Mal. Durch die Verschiebung des Blickwinkels werden Geheimnisse, die die Figu-
Seite und kämpft gegen die Ungerechtigkeiten, die sie beide erleben?
„Lars ist LOL“ erzählt eine besondere Freundschaftsgeschichte und behandelt mit Wärme und Feingefühl Themen wie Zugehörigkeit, Mobbing, Verrat und Selbstbestimmung. Der Film basiert auf dem Jugendbuch „Lars, mein Freund“ der norwegischen Autorin Iben Akerlie.

ren voreinander haben, nach und nach enthüllt. Letztlich sind die vier in ihrer Einsamkeit und Entwurzelung untergründig verbundener als sie ahnen.“
Beim „Festival des deutschen Films“ wurde „Klandestin“ in Ludwigshafen als „Bester Film“ ausgezeichnet und erhielt beim „Hamburg International Queer Film Festival“ die „Globola“ als „Bester Spielfilm“. Darüber hinaus wurde der Film beim „Hessischen Film- und Kinopreis“ mit einer Nominierung als „Bester Spielfilm“ geehrt und Barbara Sukowa mit dem Ehrenpreis des Ministerpräsidenten ausgezeichnet. pe/MiA

Eirik Sæter Stordahl (geb. 1988) arbeitet sowohl als Regisseur als auch Drehbuchautor. Er schloss 2015 sein Studium an der National Film School of Denmark mit dem Science-Fiction-Kurzfilm „In Pieces“ ab. Er lebt in Kopenhagen und arbeitet an Spielfilmen und Serien in Norwegen und Dänemark. Mit seinem Spielfilmdebüt „Lars is LoL“ widmet er sich einem emotionalen Thema und zeigt, wie Film Brücken zwischen unterschiedlichen Lebenswelten schlagen kann. Der Film kombiniert seine Stärke in der Figurenzeichnung mit einer inspirierenden Botschaft über Mut, Freundschaft und Akzeptanz. Darüber hinaus engagiert Eirik Sæter Stordahl sich neben seiner Arbeit für Bildungsprojekte und Workshops, um junge Talente zu fördern. pe/MiA


Musikalische Reise in den Mai Chorkonzert (Foto: Richard Sodmann) Fr 20.00 Uhr, Forum der Steinmühle

BIEDENKOPF
Holmes & Die Liga der Rothaarigen Hörtheater – Spannung, mit Cleverness und britischem Charme.
KONZERTE
MARBURG
ALPHAOMEGA Fest Kleines Festival über zwei Tage. Fr: WOAT, Branta, Lessoner, Bees Made Honey In The Vein Tree, Yanos.
π18.00 Café Trauma, Afföllerwiesen 3a Musikalische Reise in den Mai Chorkonzert mit Klangforum Marburg und dem Universitätschor Poitiers.
π20.00 Forum Steinmühle, Steinmühlenweg 21 Konstantin Wecker „Lieder meines Lebens“.
π20.00 Erwin-PiscatorHaus, Biegenstr. 15 Fred Hills Trio Jazz, Alt-Folk und progressiver Indie.
π21.00 Q, Pilgrimstein 2628
WETZLAR
Freundschaft, Freiheit, Frieden Konzertes für interkulturelle Austausch.
π19.00 Stadthalle Wetzlar, Brühlsbachstr. 2
π19.30 Rathaus
GIESSEN
Anaconda
Tanz von Reut Shemesh, Musik von Simon Bauer.
π19.30 Stadttheater
Gießen, Großes Haus, Südanlage 1
MARBURG
Drama für den Kopf Theater für alle Menschen ab 14.
π19.30 Hessisches Landestheater, Mini Tasch, Am Schwanhof 68-72
„Sprache ist eine Waffe. Haltet sie scharf.“
Ein Kurt-Tucholsky-Abend.
π20.00 Waggonhalle, Rudolf-Bultmann-Str. 2a
Faulpelz
Relaxed Performance von Arnita Jaunsubreena & dem solo Kollektiv almost good.
π20.00 Theater neben dem Turm, Afföllerwiesen 3a
Quichotte: „Alles echt“ Comedy/Stand-Up.
π20.00–23.00 KFZ, Biegenstr. 13
MARBURG
Aktionstag mit dem Bewegungsbus
π15.00–17.00 ChristaCzempiel-Platz
Offene Bewegungsangebote: Zumba
Die Teilnahme ist kostenlos und ohne Anmeldung möglich. Teilnahme auf eigene Verantwortung.
π16.45–17.15 Sophie-vonBrabant-Schule, Uferstr. 18
MARBURG-ELNHAUSEN
Lustige Truppe spielt jeden FR Volleyball… ...und sucht noch Mitstreiter. Bitte keine Anfänger. Mfg von MR aus möglich. Frank, 0170/1458843.
π20.00–21.45 Sporthalle Elnhausen
LESUNGEN
MARBURG
„Wie Leben geht“
Die Berliner Poetin und Sängerin Bahati Glaß liest aus ihrem Gedichtband.
π20.30 Café Roter Stern, Am Grün 28-30
PARTIES/DISCO
MARBURG
NU: Metal Party
π21.00 Knubbel, Schwanallee 27-31
Tagesaktuelle Veranstaltungen aufs Handy in unserem Telegramm-Kanal „Was geht in Marburg und Umgebung?“ t.me/expressmarburg
FOODSHARING in Marburg

Zu gut für die Tonne –Lebensmittel retten in Marburg Kostenloses Abgeben und Mitnehmen überschüssiger Lebensmittel von Privat an Privat.
Fairteiler Uni-Kirche, Reitgasse 1 Tägl. 09.00–18.00
Fairteiler Volkshochschule, Eingang Biegenstraße Mo–Do 09.00–16.00, Fr 09.00–13.00
Fairteiler Kletterhalle, Rudolf-Bultmann-Straße 4g Mo–Fr 10.00–23.00, So + feiertags 09.00–22.00
Lutherische Pfarrkirrche, Nikolai-Straße Tägl. 09.00–18.00
Fairteiler Wehrda, An der Martinskirche 1 Tägl. rund um die Uhr (Kühlschrank und Regal)

„Lieder meines Lebens“ (Foto: Thomas Karsten) Ein Abend mit Konstantin Wecker Fr 20.00 Uhr, Erwin-Piscator-Haus

FÜHRUNGEN
MARBURG
Altstadtführung
Tickets: www.marburgtourismus.de oder in der Tourist-Information.
π11.00+16.00 Treffpunkt: Marktplatz am Brunnen Die Altstadt mit Schlossbrunnen Tickets: www.marburgtourismus.de oder in der Tourist-Information.
π17.00–18.30 Treffpunkt: Marktplatz am Brunnen Schlangenwelten. (Ehr-)Furcht und Hingabe Führung anlässlich des Jahrs der Schlange.
π18.00 Religionskundliche Sammlung, LandgrafPhilipp-Str. 4
SONSTIGES
MARBURG
„Ich zeige dir meine (Ober)Stadt“ Spaziergänge für Erwachsene und Jugendliche.
π16.00 Treffpunkt: Brunnen am Markt Freitags-Workshop Unterschiedliche künstlerische Techniken kennenlernen, z.B. Malen und Zeichnen, Schablonieren, Drucken, Bauen.
π16.00–18.00 Kunstwerkstatt Marburg, Schulstr. 6
REGELMÄSSIG AM FREITAG
MARBURG
Flamenco f. Anfänger
Kontakt: jost.b@gmx.de
π17.30–18.45 Alte Mensa, Reitgasse 11
Flamenco f. Fortgeschrittene Kontakt: jost.b@gmx.de
π18.45–20.00 Alte Mensa, Reitgasse 11
ZEN-Meditation zen-qruppe-marburg.de
π18.45 ESG/RPI Marburg, Rudolf-Bultmann-Str. 4
KONZERTE
MARBURG
ALPHAOMEGA Fest Kleines Festival über zwei Tage. Sa: Shiev, Teryky, Rýr, Cranial, Yanos. π18.00 Café Trauma, Afföllerwiesen 3a
Rosalie Cunningham + Support: Amy Montgomery.
π20.30 KFZ, Biegenstr. 13
BÜHNE
GIESSEN
Grundlos vergnügt Szenische Lesung mit Musik & Texten von Mascha Kaléko. π20.00 Stadttheater Gießen, Südanlage 1
MARBURG
Zwei Herren von Real Madrid Komödie von Leo Meier. π19.30 Hessisches Landestheater, Großes Tasch, Am Schwanhof 68-72
Inga Saalmann Quintett: „An Evening With Anita O’Day“ Konzert & Lesung.
π20.00 Waggonhalle, Rudolf-Bultmann-Str. 2a Faulpelz
Relaxed Performance von Arnita Jaunsubreena & dem solo Kollektiv almost good.
π20.00 Theater neben dem Turm, Afföllerwiesen 3a
MARBURG
Lahnwiesen Parkrun
Jeden Samstag laufen, joggen & gehen wir zusammen 5km, kostenlos und mit Zeitnahme. Infos: parkrun.com.de/ lahnwiesen.
π09.00 Lahnwiesen Aktionstag mit dem Bewegungsbus π11.00–13.00 ChristaCzempiel Platz, Richtsberg π14.00–16.00 Bolzplatz Waldtal, Fuchspass
PARTIES/DISCO
MARBURG
Ü30 PARTY π21.00 Knubbel, Schwanallee 27-31
Folge uns auf Insta & TikTok!
@expressmarburg
TV-Tagestipp am Freitag

RTL 2 - 20.15 Die Unfassbaren 2
Ein Jahr nachdem die ,Vier Reiter’ das FBI überlistet & Arthur Tressler um sein Vermögen gebracht haben, stehen die Illusionisten J. Daniel Atlas, Merritt McKinney, Jack Wilder und Neuzugang Lula erneut auf der Bühne. Mit einem noch spektakuläreren Trick wollen sie die Praktiken eines Technik-Magnaten aufdecken.
MARBURG
Altstadtführung
Tickets: www.marburgtourismus.de oder in der Tourist-Information.
π11.00 Treffpunkt: Marktplatz am Brunnen
Rosa Winkel. Als homosexuell verfolgte Häftlinge in den KZ Buchenwald und Mittelbau-Dora Öffentliche Führung durch die Ausstellung mit Franziska Mendler.
π11.00 Historischer Rathaussaal, Markt 1
Das Landgrafenschloss Führung immer sonntags.
π15.00–16.00 Treffpunkt: An der Schlossmauer
Elisabethkirche, Altstadt und hinauf zum Schloss
Tickets: www.marburgtourismus.de oder in der Tourist-Information.
π15.00–17.00 Treffpunkt: Hauptportal der Elisabethkirche
Die Kasematten
Tickets: www.marburgtourismus.de oder in der Tourist-Information.
π15.15 Treffpunkt: Schlossmauer, Schaukasten
Marburg, Marburg – weißes Band, wie viel Würde an der Wand?
Spaziergang durch der Innenstadt auf der Suche nach Graffiti, Aufkleber bzw. Plakaten mit politischen Botschaften im öffentlichen Raum.
π16.00 Treffpunkt: Brunnen am Markt
SONSTIGES
MARBURG
Greenpeace Müllsammeln
Gemeinsam Müll sammeln und sich über Klimathemen austauschen.
π10.30–12.30 AbendrothBrücke
LOK Session XXL Party mit LUM!X.
π20.00 Lokschuppen, Rudolf-Bultmann-Str. 4h
REGELMÄSSIG AM SAMSTAG MARBURG
Meditation am Morgen Meditation kennenlernen und praktizieren.
π08.15–09.15 Karma Dzong Meditationszentrum e.V., Auf dem Wehr 33
GIESSEN
Lauftreff und Walking
π17.00 Treffpunkt: MTVSportplatz, Heegstrauchweg 3
KONZERTE
MARBURG
BalFolk: Airboxes Mit Tanzworkshop.
π19.00 KFZ, Biegenstr. 13 BÜHNE
MARBURG
Theater GegenStand
Märchen: Frau Holle Für Kinder ab 3 Jahren.
π15.00 Waggonhalle, Rudolf-Bultmann-Str. 2a Faulpelz
Relaxed Performance von Arnita Jaunsubreena & dem solo Kollektiv almost good.
π17.00 Theater neben dem Turm, Afföllerwiesen 3a Quälbärer Leib Gegenwartsdramatik.
π19.30 Hessisches Landestheater, Kleines Tasch, Am Schwanhof 68-72
SPORT
MARBURG
Open Sunday Bewegungslandschaften, Parcours, Spiele u.v.m. laden zum Mitmachen ein.
π10.00–14.00 Großsporthalle Richtsberg-Gesamtschule, Karlsbader Weg 3 FESTE/MESSEN
CÖLBE
Demeter Hoffest Frühlingsfest mit tollen Angeboten, Aktionen & Fleckenbühler Köstlichkeiten.
π11.00–18.00 Hof Fleckenbühl, Fleckenbühl 6 FÜHRUNGEN
MARBURG
Altstadtführung Tickets: www.marburgtourismus.de oder in der Tourist-Information.
π11.00 Treffpunkt: Marktplatz am Brunnen

Das Landgrafenschloss Tickets: www.marburgtourismus.de oder in der Tourist-Information.
π15.00 Treffpunkt: Schlossmauer, Schaukasten
SONSTIGES
EBSDORFERGRUNDBELTERSHAUSEN
Dorfflohmarkt Beltershausen Mit mehr also 100 Ständen.
π10.00–16.00 Dorf Beltershausen
GIESSEN
Flohmarkt
π08.00–15.00 Messe Gießen, An der Hessenhalle 11 MARBURG
Open Sunday Jeden ersten Sonntag im Monat.
π10.00–14.00 Sporthalle Richtsberg, GeschwisterScholl-Str. 24a
Familiencafé für Jung & Alt Mit Kinderraum und Außenspielgeräten.
π15.30–17.30 Mehrgenerationenhaus, Lutherischer Kirchhof 3
Wald fühlen und lesen gehen Waldspaziergang mit Konstantinos-Antonios Goutos aka „der WaldGänge®“.
π16.00 Treffpunkt: Marktplatz am Brunnen
SPORT
MARBURG
Offene Bewegungsangebote: Pilates
Die Teilnahme an den Offenen Bewegungsangeboten ist kostenlos und ohne Anmeldung möglich.
π17.30–18.00 Auf der Weide, Auf der Weide
Offene Bewegungsangebote: Starker Rücken für alle
Die Teilnahme ist kostenlos und ohne Anmeldung möglich. Teilnahme auf eigene Verantwortung.
π18.00–19.00 Nachbarschaftszentrum Waldtal, Waidmannsweg 11
Offene Bewegungsangebote: Fit durch den Sommer
Die Teilnahme ist kostenlos und ohne Anmeldung mög-
Super RTL - 22.00 Kiss & Kill
Spencer und Jen haben sich auf einer Reise durch Südfrankreich kennengelernt und heiraten bei ihrer Rückkehr nach Amerika. Sie wirken wie ein ganz normales Paar und nicht einmal Jen ahnt, dass Spencer einmal als Agent und Auftragskiller gearbeitet hat.
Rosalie Cunningham (Foto: Rob Blackham) Support: Amy Montgomery Sa 20.30 Uhr, KFZ



lich. Teilnahme auf eigene Verantwortung.
π19.00–20.00 Nachbarschaftszentrum Waldtal, Waidmannsweg 11
WALDTAL
Offene Bewegungsangebote: Bewegungsangebot für Grundschulkinder
Die Teilnahme ist kostenlos und ohne Anmeldung möglich.
π16.00–18.00 Bolzplatz am Fuchspass
FÜHRUNGEN
MARBURG
Altstadtführung
Tickets: www.marburgtourismus.de oder in der Tourist-Information.
π11.00 Treffpunkt: Marktplatz am Brunnen
SONSTIGES
MARBURG
Schwule Theke Offener Stammtisch für LGBT*IQA+ und Freunde KFZ, Biegenstr. 13
Welthebammentag öffnet seine Türen 12 erfahrene Hebammen begleitenMenschen rund um das Elternwerden und darüber hinaus.
π16.00–18.00 Geburtshaus, Schwanallee 31
[Video]flanieren gehen
In diesem Walkshop erhalten Sie eine „kompakte Einführung“ in das [video]flanieren.
π16.00 Treffpunkt: Brunnen am Markt
Figuren-Malworkshop und Tabletop-Stammtisch Kostenloser Bemalworkshop für eure Miniaturen. Weitere Informationen auf www.gamersit.de.
π16.00 Game It Spielwaren, Biegenstr. 37 Workshop:Aquarellieren und Experimentieren Wir tauchen ein in eine Welt voller Farben, üben uns in verschiedenen Techniken der Aquarellmalerei und entdecken die Farbverläufe passend zum Frühling.
π16.45–18.15 Kunstwerkstatt Marburg, Schulstr. 6
After-Work-Atelier Offenes Atelier für Erwachsene.
π19.00–21.00 Kunstwerkstatt Marburg, Schulstr. 6
REGELMÄSSIG AM MONTAG MARBURG
Beratungstelefon Rund um Schwangerschaft: 06421/200874
π12.30–13.30 pro familia, Frankfurter Str. 66
Chorprobe des Ev. Kirchenchores Cappel www.kirchenchor-cappel.de.

In den Schulferien keine Proben!
π18.15–19.45 Paul Gerhardt Haus, Zur Aue 2 GIESSEN
Lauftreff und Walking
π19.00 Treffpunkt: MTVSportplatz, Heegstrauchweg 3
BÜHNE
MARBURG
Prima Facie Monolog nach Suzie Miller. π19.30 Hessisches Landestheater, Großes Tasch, Am Schwanhof 68-72
Marburger Science Slam Wissenschaft trifft Entertainment! π20.00 Waggonhalle, Rudolf-Bultmann-Str. 2a SPORT
MARBURG
Offene Bewegungsangebote: Tai Chi/Qi Gong Die Teilnahme ist kostenlos und ohne Anmeldung möglich. Teilnahme auf eigene Verantwortung. π16.30 Auf der Weide
am Sonntag
RTL - 20.15 Jurassic World
22 Jahre nach Jurassic Park sucht der Gründer nach spektakuläreren Attraktionen. Aus dem Park von einst, wurde Jurassic World & neue Erkenntnisse in der Genforschung lassen immer interessantere Dinosaurier mutieren. Als der Hybrid Indominus Rex entsteht, erfährt die Harmonie im Park ein jähes Ende.

Quälbarer Leib (Foto: Jan Bosch) Gegenwartsdramatik So 19.30 Uhr, Kleines Tasch


MARBURG-RICHTSBERG
Aktionstag mit dem Bewegungsbus
π16.00–18.00 Garagenhof, zwischen Friedrich-EbertStraße und Damaschkeweg
LESUNGEN
GIESSEN
„Wie viel: Was wir mit Geld machen und was Geld mit uns macht“
Mit der Journalistin Mareice Kaiser. Anmeldungen über www.jbw-giessen.de
π19.00 Jokus, Ostanlage 25a
VORTRÄGE
MARBURG
Kinder und Jugendliche vor digitaler sexualisierter Gewalt schützen
Anmeldung bis 4.5. unter vhs.link/ScGRtD.
π18.30–20.30 Online
„Cybergrooming“
Online-Infoabend für Eltern.
π18.30–20.30 Kreisverwaltung Marburg-Biedenkopf, Im Lichtenholz 60
FÜHRUNGEN
MARBURG
Altstadtführung
Tickets: www.marburgtourismus.de oder in der Tourist-Information.
π11.00 Treffpunkt: Marktplatz am Brunnen
SONSTIGES
KIRCHHAIN
Mobile KunstWerkStattDie Kunst-Koffer kommen Wir reisen mit Koffern voller Ton, Farben, Holz und Werkzeug zu öffentlichen Plätzen im Freien und laden alle Kinder und Jugendliche ein.
π15.00–17.00 Anna-Park MARBURG
„Drop in(klusive)“ Offene, kostenfreie & internationale Eltern-KindGruppe (für Kindern unter drei Jahren) mit Frühstück.
π09.30–11.30 Ev. Familienbildungsstätte, Treffpunktraum, Universitätsstr. 59
Offenes Stillcafé: „Die Stillerei“ …mit Frühstück. Anmeldung bitte unter 0173/ 7170724, Christina Rau.
π09.30–11.00 Mehrgenerationenhaus, Lutherischer Kirchhof 3
„Fotografieren ohne Kamera“ Ein Foto-Walk der ganz besonderen Art. Nähere Infos unter www.konstantinosantoniosgoutos.art.blog
π16.00 Treffpunkt: Brunnen am Markt
Offene Bewegungsangebote:
Yoga Die Teilnahme ist kostenlos und ohne Anmeldung mög-

Marburger Science Slam (Foto: Pexels) Wissenschaft trifft Entertainment Di 20.00 Uhr, Waggonhalle
lich. Teilnahme auf eigene Verantwortung.
π17.00 Nachbarschaftszentrum Waldtal, Waidmannsweg 11 Zeichenkurs für Kinder In diesem Kurs erlernen junge Künstler grundlegende Zeichentechniken.
π17.00–18.30 Kunstwerkstatt Marburg, Schulstr. 6 Offener SammelkartenspielAbend für Alle mit Late Night Shopping Kostenloser Spieleabend mit langer Öffnung für alle Sammelkartenspieler, z.B. Magic the Gathering Commander Runden. Weitere Infos auf www.gamersit.de.
π18.00 Game It Spielwaren, Biegenstr. 37 Kommunalpolitischer Arbeitskreis der Ortenberggemeinde (KopAK) Öffentliche Sitzung.
π19.00 Gemeinschaftshaus der Ortenberggemeinde, Rudolf-Bultmann-Str. 7 WETZLAR
Dienstagsmärchen Spezial: Europawochen Märchen und Geschichten aus Frankreich. Voranmeldung wird empfohlen: isabell.kurz@wetzlar.de; mail@phantastik.eu, Tel.: 06441 40010.
π17.00 Phantastische Bibliothek, Turmstr. 20
www.marbuch-verlag.de
Kabel 1 - 22.30 Miami Vice
Weil FBI-Agenten bei einem Undercovereinsatz verraten wurden und starben, ermitteln die Cops Crockett und Tubbs verdeckt. Um den Maulwurf und Drogenabnehmer in Südflorida zu orten, geben sie sich als Drogenkuriere aus, die die Ware aus Südamerika sicher ins Land bringen.

KONZERTE
MARBURG
Frank’s White Canvas Frauen-Rockduo aus Chile.
π21.00 Q, Pilgrimstein 26-28
GIESSEN
Biyon Kattilathu: „Eine Reise zum Glück“ Inspirierende Unterhaltung für mehr Leichtigkeit und spürbares Glück. π20.00 Kongresshalle Gießen, Südanlage 3
MARBURG
Our!Stage Open Stage für FLINTA*, im Anschluss Party bis 22 Uhr. FLINTA* only! π18.00 Café Trauma, Afföllerwiesen 3a
MARBURG
Offene Bewegungsangebote: Herz-Kreislauf-Training Die Teilnahme ist kostenlos und ohne Anmeldung möglich. Teilnahme auf eigene Verantwortung. π17.30–18.00 Lahnwiesen, Höhe Affenfelsen

VORTRÄGE
MARBURG
Fachvortrag: „Ernährung und Krebs“ Was hilft wirklich? Ernährung während und nach einer Krebserkrankung.
π17.00 Cineplex, Biegenstraße 1a
MARBURG-WEHRDA
SlowFood. Gute, saubere, faire Lebensmittel für alle Ref.: Christian Weingran. Eintritt frei.
π18.00 LebensMittelPunkt Zentrum, An der Martinskirche 1
MARBURG
Bar Bachelor
Abschlusslocation: Knubbel Marburg!
π22.00 Knubbel, Schwanallee 27-31 FÜHRUNGEN
MARBURG
Altstadtführung
Tickets: www.marburgtourismus.de oder in der Tourist-Information.
π11.00 Treffpunkt: Marktplatz am Brunnen SONSTIGES
MARBURG
Meetingpoint Elterncafé für Eltern mit kleinen Zwergen.
π10.00–11.00 Mehrgenerationenhaus, Lutherischer Kirchhof 3

Mobile KunstWerkStattDie Kunst-Koffer kommen Wir reisen mit Koffern voller Ton, Farben, Holz und Werkzeug an öffentlichen Plätzen im Freien und laden alle Kinder und Jugendliche ein.
π15.00–17.00 Rudolphsplatz
„OberWerkStadt“ Spaziergänge für Erwachsene und Jugendliche.
π16.00 Treffpunkt: Brunnen am Markt Tonwerkstatt Ihr könnt verschiedene Techniken ausprobieren und vor dem Brennen eure Werke noch farbig glasieren.
π16.30–18.00 Kunstwerkstatt Marburg, Schulstr. 6 Wenn das Ende zum Anfang wird
In stimmungsvoller Atmosphäre werden Fragen von Perspektivität, Zwischenwelten und Verwandlung zur Ausstellung „Metamorphosis“ von C. A. Barnikol besprochen.
π19.00–21.00 KA.RE. Marburg, Biegenstraße 18a REGELMÄSSIG AM MITTWOCH MARBURG
Meditation am Morgen Meditation kennenlernen und praktizieren.
π08.00–09.00 Karma Dzong Meditationszentrum e.V., Auf dem Wehr 33 Marburger Chor 1949 e.V. www.marburger-chor.de
π19.00 Hansenhausgemeinde, Gerhardt-Hauptmann-Str. 1
Tele 5 - 20.15 Ex Machina
Caleb Smith arbeitet als Programmierer bei der weltweit erfolgreichen Internetsuchmaschine „Blue Book“. Durch ein firmeninternes Gewinnspiel erhält er die Möglichkeit, dem Firmengründer Nathan Bates bei seiner Arbeit an einer neuen Entwicklung über die Schulter zu schauen.
Frank’s White Canvas (Foto: Frank’s White Canvas)
Frauen-Rockduo aus Chile
Mi 21.00 Uhr, Q


GIESSEN
Lauftreff und Walking
π19.00 Treffpunkt: MTVSportplatz, Heegstrauchweg 3
DONNERSTAG
KONZERTE
MARBURG
Gregor Meyle: Wohnzimmerkonzerte-Tour 2025 Tournee in kleiner Besetzung durch ausgewählte Locations.
π20.00 Erwin-PiscatorHaus, Biegenstr. 15 Colosseum: „Out Into The Fields“-Tour Jazz-Rock.
π20.30 KFZ, Biegenstr. 13 BÜHNE
MARBURG
„Vinter“
Multimediale Inszenierung nach der Vorlage von Literaturnobelpreisträger Jon Fosse.
π20.00 Waggonhalle, Rudolf-Bultmann-Str. 2a SPORT
MARBURG
Offene Bewegungsangebote: Bewegtes Trommeln Die Teilnahme ist kostenlos und ohne Anmeldung möglich. Teilnahme auf eigene Verantwortung.
π18.00–18.30 AugustBebel-Platz
VORTRÄGE
MARBURG
Die Freien Waldorfschulen im Nationalsozialismus
Ref.: Prof. Dr. Peter Selg.
π19.00 Aula der Freien Waldorfschule, Ockershäuser Allee 14
FESTE/MESSEN
MARBURG
Feierabendtreff - After Work Oberstadt Nach einem langen Arbeitstag bei entspannter Musik regionale Köstlichkeiten genießen und dabei neue Leute kennenlernen.
π17.00 Heumarkt
FÜHRUNGEN
MARBURG
Altstadtführung
Tickets: www.marburgtourismus.de oder in der Tourist-Information.
π11.00 Treffpunkt: Marktplatz am Brunnen SONSTIGES
MARBURG
Mixed-Media Malkurs Kreatives Gestalten mit und ohne Vorerfahrung. Infos/Anmeldung: www.alles-kreativ.de.
π10.30–12.00 Elisabeth Therapeutikum, Friedrich Naumannstraße 9
RepairCafe Marburg Mitte Reparieren statt wegwerfen. Anmeldung unter:

www.solidarburg.de/ materialzentrum-marburg/ reparierbar.
π15.00–18.00 MaZe Marburg, Biegenstr. 17
Eltern-Kind-Trommelkurs
Schnupperstunde Für Kinder von 8 bis 12 Jahre. Anmeldung unter: www.trommelklang.art
π16.00–17.00 Trommelschule Marburg, Bahnhofstraße 31A
„MrGrBot Mobil“ Spaziergänge für Erwachsene und Jugendliche.
π16.00 Treffpunkt: Brunnen am Markt
Elterninformationsabend rund um die Geburt www.ukgm.de//ugm_2/deu/ umr_gyn/30066.html
π18.00 Online
Einführung in die Buddhistische Meditationspraxis Mit Gedichten des ZenPoeten Gary Snyder zum 95. Geburtstag.
π18.45 Buddhistische Gruppe Marburg, Biegenstraße 20
TrommelkursSchnupperstunde Für Anfänger. Anmeldung: www.trommelklang.art.
π19.30–21.00 Trommelschule Marburg, Bahnhofstraße 31A
REGELMÄSSIG AM DONNERSTAG MARBURG
Offenes Meditationsangebot Gelassenheit im Alltag, für Anfangende & Fortgeschrittene.
π18.30–20.00 Karma Dzong Meditationszentrum e.V., Auf dem Wehr 33
3sat - 22.25 Klondike

Gregor Meyle (Foto: Charlie Spieker) Wohnzimmerkonzerte-Tour Do 20.00 Uhr, Erwin-Piscator-Haus


Irka und Tolik leben in einem kleinen Dorf an der ukrainisch-russischen Grenze. Gleichzeitig sehen sich jedoch mit den intensiver werdenden kriegerischen Handlungen zwischen separatistischen Milizgruppen, die von Russland unterstützt werden, und der ukrainischen Armee konfrontiert. TV-Tagestipp am Donnerstag

Das Erste - 20.15 Der Amsterdam-Krimi
In Amsterdam entkommt die illegal eingereiste Safiya einer kriminellen Organisation, die sie im Tausch gegen Schlepperdienste zur Organspende zwingen wollte. Ihre kleine Schwester bleibt in den Händen der Verbrecher zurück. Die Ermittler Bram und Alex sind dem Gangsterboss Dewi auf der Spur.
Edelsteine von
Grüner FUCHSIT –der geistig Bewegliche



l Suche Hilfe bei Wohnungseinrichtung kompetente und fleißige Hausfrau. Ebenso einen handwerklich be-
gabten Rentner oder Frührentner. Mobilität und Führerschein erforderlich. Tel.: 0173/ 2663750 (Anrufe ab 18 Uhr).
l Transporte aller Art mit DB Sprinter, europaweit. 0157/89048423. (gewerbl.)
l Suche junge Frau/Studentin, die 2x pro Woche vormittags etwas mit meiner Tochter (Downsyndrom) unternimmt. Tel: 06420/1658
l Geschwisterkinderwagen gesucht für Flüchtlingsfamilie. 0160/ 97327935.
l Frau Desiree kauft Aussteuer Gebelin Arbeiten, Leinen und jegliche Art von Handarbeiten, Modeschmuck und Nähmaschinen. Tel: 0176/20194470
l Wohnungs- u. Werkstattflohmarkt. Marburg, Pilgrimstein 13. Fr. 02. Mai von 15-18 Uhr. Sa. 03. Mai von 1016 Uhr
l Umzugkartons (Profiqualität) pro 10 STK/28 Euros Abholung MR Mitte 0172/5200929
l MARBUCH – Marburgs Stadtbuch gibts jetzt für nur 6,99 (statt 14,90) im Buchhandel oder direkt beim Verlag, Ernst-Giller-Str. 20a (Nähe Bahnhof). (gewerbl.)
l Bett 100x200cm, Gestell Kiefer massiv, schon älter. Matratze und Lattenrost 5 Jahre alt 1a Zustand. Taschenfederkern, Lattenrost härteverstellbar. Original Rechnung liegt vor. Kontakt: Tel 0160/6604519, auch WhatsApp/Signal
l Transporte aller Art mit DB Sprinter, europaweit. 0157/89048423. (gewerbl.)
l Gesprächstherapie und lösungsorientierte Beratung für Einzelpersonen, Paare, Familien und Gruppen, Emotionale Körpertherapie, Trennungs- und Trauerberatung, Frauenheilkunde, Irisdiagnose und Konstitutionsmedizin, Homöopathie und Schüßlersalze. Simone Moter, Gesprächstherapeutin und Heilpraktikerin, www.moter.de, 06421/ 983705.
l „Paarprobleme? Psychisch am Limit?“ SOFORTHILFE auf dem Weg zu emotionaler Gesundheit und einer liebevollen und respektvollen Beziehung. Kurzfristige Termine! Heilpraktiker Psychotherapie und Paartherapeut Helmut Konnerth, 0171/ 9308449, www.info-praxiskonnerth. de (gewerbl.)
l MARBUCH – Marburgs Stadtbuch gibts jetzt für nur 6,99 (statt 14,90)
im Buchhandel oder direkt beim Verlag, Ernst-Giller-Str. 20a (Nähe Bahnhof). (gewerbl.)
l Biete Umzugshilfe und Entrümplungen mit Transporter. Studententarife!!! www.moebelmoving.de, 0171/9970242. (gewerbl.)
l Nicht versäumen! Frühlingshafter Flohmarkt in der Markthalle Kirchhain am Samstag, den 10.05.25 von 8-14 Uhr. Besucher und Händler herzlich willkommen. Aufbau ab 6.30 Uhr. Anmeldung unter: 0171/ 2039017
l Ich suche eine Arbeit als Maurer, für Fliesen legen, Pflasterarbeiten, Trockenbau, Putz- und Gartenarbeiten. Tel: 0176/45089691
l Suche Haushaltshilfe auf Minijobbasis für 5 Std./Woche, Tage flexibel (Mo, Di, Mi, Fr, Sa), in 35039 Marburg; 06421/25935.
l Suche Minijob (Putz-/Haushaltshilfe, Fenster putzen...) im Raum Marburg. Kontakt: 0152/08519448.
l Unser Islandpferdehof „BurgwaldTrekking“ sucht für unsere SommerReitfreizeiten (06.07-12.07.2025/ 1.Ferienwoche und 13.07-19.07. 2025 - 2. Ferienwoche) Betreuer/innen. Wir bieten täglich zwei Reitstunden, eine Unterkunft und Ver-

Regeln:
Sie die leeren Felder so aus, dass einmal
in jeder Zeile
in jeder Spalte
in jedem 3 x 3 Kästchen alle Zahlen von 1 bis 9 stehen.
Schwierigkeit: mittel n n nn
Lösung einsenden - und gewinnen!
Unter allen richtigen Einsendungen verlosen wir 4 x 3 Kleinanzeigen (privat an privat).
Und ab geht die Post an: Marburger Magazin Express - SudokuErnst-Giller-Str. 20a 35039 Marburg
oder per E-Mail an: kaz@marbuch-verlag.de
Lösung aus Ausgabe 17/25
pflegung und vieles mehr. Das Reitprogramm wird von unseren Trainern/innen geleitet, daher sind reiterliche Vorkenntnisse nicht zwingend erforderlich. Weitere Infos findest Du auf unserer Homepage www.burgwald-trekking.de Interesse? Schick uns ein Mail! (gewerbl.)
l Yogalehrer/in werden. Die neue Ausbildung beginnt im Januar 2026. Infos unter info@yoga-balance.de oder 06421/9790575.
l Textcollage – Kraft der Schnipsel. Wir machen uns die Worte anderer zu eigen. Fr. 16.05. von 17.00-19.00 Uhr. Info und Anmeld.: Andrea Saalbach. www.sprachspielraum.de (gewerbl.)
l Neue spirituelle Schreibwerkstatt beginnt Mi. 14.05. 16.00-18.00 Uhr, Haspelstr.9. Info und Anmeld.: Andrea Saalbach. www.sprachspielraum.de (gewerbl.)
l Buddhistisches Meditationszentrum e.V. hat einen schönen hellen Raum (ca. 100qm) in Weidenhausen/MR zu vermieten, zzgl. Küchenund WC-Mitbenutzung. Parkplätze vorhanden. Kontakt: helmutjohann@ gmail.com, Tel. 0177/716 4638.
l Y O G A – Kurs für Anfänger, von Krankenkasse anerkannt; ab 05.05. 25, montags 9.30-11.00 Uhr, im Meditationszenrum MR-Weidenhausen, kostenlose Schnupperstunde, Tel.: 06420/826680, www.haroldjunge.de (gewerbl.)
l MARBUCH – Marburgs Stadtbuch gibts jetzt für nur 6,99 (statt 14,90) im Buchhandel oder direkt beim Verlag, Ernst-Giller-Str. 20a (Nähe Bahnhof). (gewerbl.)
l MEIN PLATZ IN MEINEM LEBEN. SYSTEMAUFSTELLUNGEN zur Klärung von Beruf, Familie, Partnerschaft, eigener Geschichte – Wege zu meinem guten Platz im Leben. 03.05.2025, 14.00-19.00. Systemische Therapie und Beratung Dariusch Milani. Anerkannter Systemaufsteller (DGfS). Info/Anmeldung: 06423/541120, mail@dariusch-milani. de, www.systemaufstellungen-milani. de (gewerbl.)
l Anerkennen, was ist und finden, was heilt! Familienaufstellungen am 24.05.2025 und 13.09.2025 in Marburg mit Margit Giesen und Samuel Koelewijn. Alle Informationen und Anmeldung unter: WEB: www.koelewijn.de – Mail: Aufstellungsarbeit@ gmx.de Telefon: 01590/ 1362339 (gewerbl.)
l Biete schöne Räume für versch. Workshops in ausgeb. Scheune. Ländl. Raum, 12 km von MR/Weimar/Nesselbrunn für ca. 10 Pers.
www.ton-und-steine.de, Tel. 06420/ 826822
l Y O G A – Kurs für AnfängerInnen, von Krankenkasse anerkannt; ab 05.05.25, montags 9.30-11.00 Uhr, im Meditationszenrum MR-Weidenhausen, kostenlose Schnupperstunde, Tel.: 06420/826680, www. harold-junge.de (gewerbl.)
l Tango Argentino: Ab dem 3. Februar beginnen wieder neue Tango Argentino Kurse in Marburg. Anfänger Montags um 19.00 Uhr und Fortgeschrittene um 20.15 Uhr. Anmeldung und weitere Informationen bei Roland Girards Telnr.: 0176/22616798 (gewerbl.)
l „Marburger Musen“ – ein Schreibretreat für Frauen*. – In dir steckt eine Geschichte, die nur du erzählen kannst. Tritt in die Fussstapfen schreibender Frauen und finde deine eigene Stimme. Vom 30.Mai-01.Juni 2025 im „Haus der Romantik“ in Marburg. Jetzt anmelden! Infos unter www.claudia-scheidemann.de –Die Schreibapotheke® (gewerbl.)
l Der Frauennotruf Marburg e.V. bietet Beratung bei Vergewaltigung, Belästigung, Stalking und anderen Grenzüberschreitungen. Telefonische Beratung Mo 16-18 Uhr & Do 9-11 Uhr unter 06421/21438. Persönliche Beratung nach Termin. Offene Beratungssprechzeit im BiP (Am Grün 16) Di 11.30-13.30 Uhr (berollbar). Mobile Beratung zu Hause oder an einem anderen Ort möglich. www.frauennotruf-marburg.de.
l Berghütte am Kristberg für 2-4 Personen auf 1.100 Meter Höhe in Österreich (Montafon, Silbertal) zu vermieten. Wunderbares Wanderund Winter-Sportgebiet. Hüttenpreis pro Nacht 60,- EUR + NK für 2 Personen (weitere Personen je 10,EUR). Astrid Gabl, Tel.: 0043/664/ 5922292, e-mail: thomas.gabl3@ gmx.at
l MARBUCH – Marburgs Stadtbuch gibts jetzt für nur 6,99 (statt 14,90) im Buchhandel oder direkt beim Verlag, Ernst-Giller-Str. 20a (Nähe Bahnhof). (gewerbl.)
l AIKIDO trad. japanische Kampfkunst. www.aikikai-marburg.de
l Gesucht wird schnellstmöglich eine 3 ZKB-Wohnung (ab 50 m2) oder Haus auf Miete mit Garten – optional auch Kauf in z.B. Marburg, Amöne-
Suche engagierte Mitarbeiter/innen als Aushilfe im Imbissbetrieb auf unseren Festen.

Tel. 0171/4717479

Reisen - regional & schwarz auf weiß!
Tel.: 06421-6844-68 • Fax: 06421-6844-44
Online: marbuch-verlag.de






burg, Lahntal oder Richtung Gießen gesucht. Hundehaltung sollte erwünscht sein. Kontaktaufnahme gerne per SMS. Tel. 0179/6603776. Ich melde mich dann.
l Transporte aller Art mit DB Sprinter, europaweit. 0157/89048423. (gewerbl.)
l MARBUCH – Marburgs Stadtbuch gibts jetzt für nur 6,99 (statt 14,90)
im Buchhandel oder direkt beim Verlag, Ernst-Giller-Str. 20a (Nähe Bahnhof). (gewerbl.)
l Er sucht spontane offene Sie für dauerhafte Freundschaft. Gerne gebunden. 100 % Diskretion. Tel. 0177/7069118
l Kaufe PKW, Geländewagen, Busse aller Art an. Egal ob Unfallod. Motorschäden, ohne TÜV und hohe Km-Zahl. Umweltplakete, BJ spielt keine Rolle. Bitte alles anbieten. 0172/7881362. (gewerbl.)
l Er 49, gut aussehnt, sucht nette Sie für Erotische Treffs, gerne auch älter. Kontakt: 0151/17623784
l Er freundlich, sucht Kontakt zu Frauen zum Treffen und viel Spaß haben. 0172/4976367.
l MARBUCH – Marburgs Stadtbuch gibts jetzt für nur 6,99 (statt 14,90) im Buchhandel oder direkt beim Verlag, Ernst-Giller-Str. 20a (Nähe Bahnhof). (gewerbl.)
l Transporte aller Art mit DB Sprinter, europaweit. 0157/ 89048423. (gewerbl.) 0172/ 7881362. (gewerbl.)
l Suche ein automatisches Auto zum verrichten. 017679792572 auch SMS.

KUNSTRADLER*INNEN FITNESS-CREWS SPORTLER*INNEN Die Drachenboot-Bühne an der Lahn bietet Euch eine Auftrittsmöglichkeit beim Stadtfest 3TM!
ANMELDUNG:
Marbuch Verlag „Sportler*innenbühne”
Post : Ernst-Giller-Str. 20a, 35039 Marburg
Tel : 06421 / 68 44 0
Fax : 06421 / 68 44 44
Online : www.marbuch-verlag.de/anmeldungen/sportlerinnen >>


